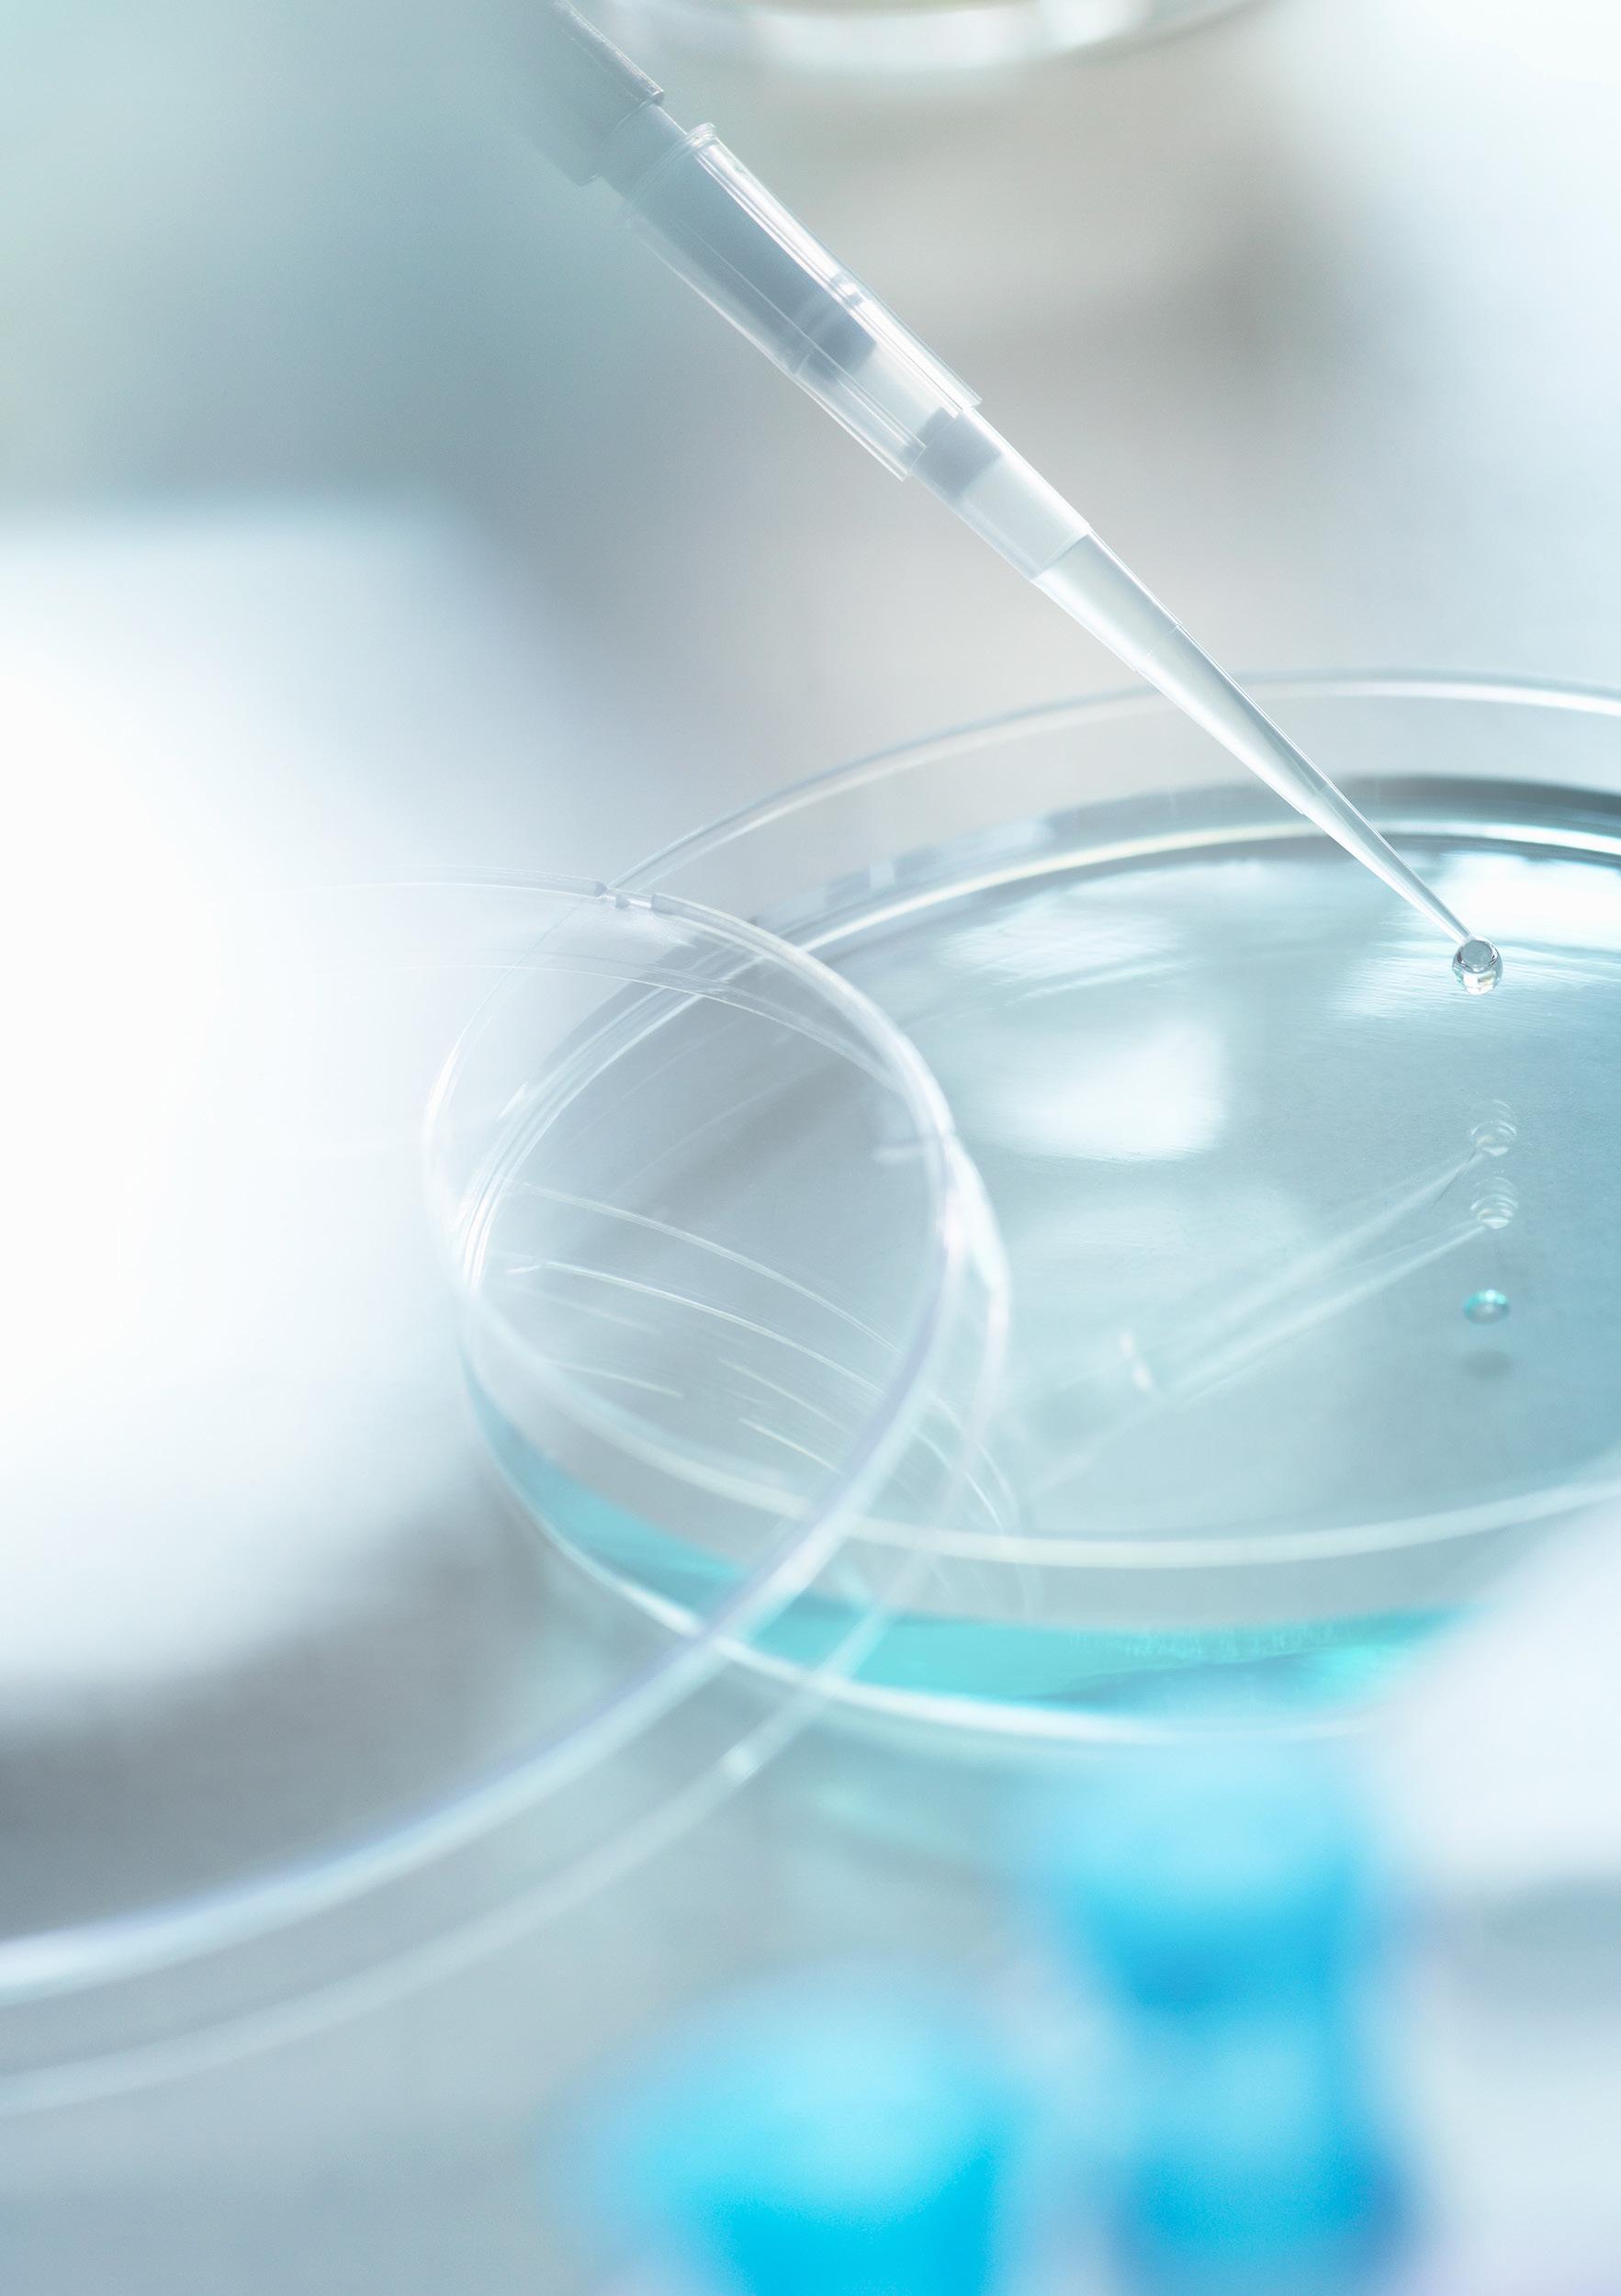

Sõna „zinzino“ tähendab väikest osakest, millel on suur väärtus.
Meie jaoks olete hindamatu. Just seepärast on meie eesmärk tuua igas inimeses välja nende parim mina.
Inspire Change in Life
Sisukord


![]()



Sõna „zinzino“ tähendab väikest osakest, millel on suur väärtus.
Meie jaoks olete hindamatu. Just seepärast on meie eesmärk tuua igas inimeses välja nende parim mina.


Olete teinud suurepärase otsuse. Meil on ülimalt hea meel, et nüüdsest kuulute meeskonda, mille missiooniks on innustada oma kliente, perekonda, sõpru liikuma parema tervise ja suurema sissetuleku poole.
Alternatiivne karjäär
Meie pakutud alternatiiv on paindlikum, annab teile rohkem valikuid ning keskendub teie elule vastavalt teie esitatud tingimustele. Valik on teie teha. Paljud inimesed eelistavad alustada Zinzinoga koostööd osalise tööajaga - 10–15 tundi nädalas. Osad on rõõmsad, kui saavad Zinzino abil luua endale lisasissetuleku, aga enamasti luuakse siin endale uus karjäär, mis annab rohkem aega, paindlikkust ning finantsvabadust, mida vajatakse oma unistuste elu elamiseks.
Oma äri ülesehitamine nõuab pingutusi ja aega. Meie ärimudeli juures on unikaalne see, et tavalise äri alustamiseks vajaliku investeerimiskapitali saab siin asendada ajalise investeeringuga. Eesmärgipäraselt töötades võite 3–5 aastaga rajada omale organisatsiooni, mis annab teile võimaluse elada oma elu just selliselt nagu te ise soovite.
„Mis siis kui kuskil oleks olemas alternatiiv 40 aastat 40 tundi nädalas töötamisele?“


Need on meie põhiväärtused, mis defineerivad meie ettevõtte ainulaadset kultuuri ja näitavad maailmale, kes me oleme, mille eest seisame ja millesse usume. Laske neil end igapäevases töös juhtida, et luua usaldust, ustavust ja jätkuva eduga äri.
Meie visioon: Pakume inspiratsiooni elumuutusteks!
Meie missioon: Innustame oma kliente, perekonda, sõpru liikuma parema tervise ja jõukuse poole. Olles kõige kliendisõbralikum otsemüügiettevõte maailmas. Iga päev.
Meie eesmärgid:
Saavutada 2035. aasta lõpuks kliendibaasiks
20 miljonit klienti.
Saavutada 2050. aasta lõpuks kliendibaasiks
100 miljonit klienti.
Teekond parema tervise poole on personaalne.
See pole äraarvamismäng.
Te olete ainulaadne.


Teie teekond algab meie tervisetestidega. Nii toome teid ja kogu maailma tagasi tasakaalu.
„Oleme testipõhise, personaalse toitumise teerajajad virmaliste, keskööpäikese, sügavate fjordide ja kõrgete mägede maalt.“




Jaga parimaid Zinzino lugusid
Kutsume üles kõiki loomult andekaid jutuvestjaid! Nagu teate, siis otsemüügi saladus peitub lugude jagamises - lood, mis räägivad suurepärastest toodetest ja uutest ärivõimalustest. Seepärast anname teile Zinzino kaubamärgi lugude raamatu! Ehitage oma äri, jagades parimaid lugusid meie ainulaadse kultuuri, eesrindlike põhipakkumiste ja murranguliste toodete kohta meie portfellis!
Võtke seda kui oma isiklikku sissevaadet sellele, kuidas meie BalanceOil+ tegi kogu tööstuses revolutsiooni ja kuidas meie BalanceTest muutis isikustatud tervise tuleviku ja viis Zinzino otsemüügi järgimisele tasemele. Et oleksite kursis kõigega, millest rääkida, lisasime ka kiired ja lihtsad moodused, kuidas meie põhiväärtusi, eesmärki ja lubadusi jagada ning muidugi sõnumid toodete kohta, mis on nii asjakohased kui ka mõjusad!

Peame neid järgima. Teist moodust pole
Kui sõidame autoga, siis ootame, et teised autod jääksid punase tulega seisma, kui on meie kord sõita. Täpselt nagu nemad eeldavad, et meie ootaksime ringristmikul enda korda. Kui me selliseid asju iseenesest mõistetavalt ei saaks võtta, oleks autoga sõitmine väga ebaturvaline ja ohtlik. Zinzino süsteem on rajatud sarnasele lihtsale põhimõttele. Peame kõik tegema oma osa, et teekond millel me koos oleme, oleks tõeliselt meeldiv ja ohutu. Liitumisel allkirjastatud partner lepingus väljatoodud käitumiskoodeksi järgimine on kõige olulisem moodus, et kindlustada meile terve ja elujõuline kogukond.
Tee on selge, kui teil on teeviidad olemas
Üksteise vastu austuse üles näitamine ja aktsepteerimine, et me kõik ajame äri erinevat moodi, ei ole see, mis meid eristab. See ühendab meid.
Teie parimad tavad võivad teiste omadest erineda mõned võivad alustada toodetest, teised ärist. Mõned keskenduvad BalanceOilile, teised Terviseprotokollile. Oleme kõik samas äris ja meil on omad moodused, kuidas seda edukalt teha. Mõned meist võivad kiiremini tulemusi saavutada, kuid see ei pruugi tähendada, et nende meetodid on paremad. Ilmselt on neil rohkem kohtumisi ja rohkem kogemusi. Ilmselt nad tegid algusest peale koostööd ambitsioonikate inimestega. Ka teie saavutate edu, kui järgite parimaid praktikaid, mida õpetab teile teie ülaliin, ja jääte truuks põhiväärtustele, mida jagame Zinzino partneritena. Jagage juba algusest peale positiivset sõnumit. Meie ühiste põhimõtete järgimine aitab teie organisatsioonil ja võrgustikul kasvada. Aidake meil jagada meie põhiväärtusi ja käitumiskoodeksit kõikide uute inimestega, kes võrgustikku tuuakse ka siis, kui seda teeb keegi teine.
Vältige takistusi. Vältige igal juhul ristvärbamist
Pole lubatud püüda värvata kedagi ühest oma liinist oma teise liini või kedagi mõnest teisest ristliinist mõnda enda liini. Karistuseks on koostöö lõpetamine, mitte ainult värvatavale inimesele, aga ka sponsorile ja potentsiaalselt mitmele ülaliini inimesele, kui nad tegevusest osa võtsid.
Hoidke see teekond ohutu, lõbus ja meie visioonile truu
Veenduge, et olete kursis partneri lepingu sisuga, meie turunduseeskirjade ja eetika dokumentidega meie Back Office'is.
Kannate meie põhiväärtusi endaga kaasas
Pidage meeles, et just teie ise olete meie kõige olulisem saadik.
Kehastate Zinzino eesmärki ja lubadust. See, kuidas end igapäevaselt näitate, määrab meie ettevõtte kultuuri. Olge parim versioon iseendast, kes seisab meie eesmärkide ja uskumuste eest! Rääkige hästi enda ülaliinist, enda meeskonnast ja ristliinidest. Õnnitlege teisi inimesi nende edu puhul ja nemad teevad teie jaoks sama. Nii annamegi inspiratsiooni elumuutusteks!
Tere tulemast meeskonda
Meie esmane koolitus (Get Started) koosneb neljast osast, kas videona või tunniajase kohtumisena, kus keskendume sellele, et õpetada teile põhilisi mooduseid oma äri alustamiseks.
Pidage meeles, et konkreetse eesmärkidega plaani tegemine on edu seisukohalt ülioluline. Olgugi, et me õpetame teile, kuidas äriga alustada, võtke aega, et koostada eesmärkidega plaan kas iseseisvalt või koos sponsoriga, kohtumise ajal või pärast kohtumist.





Kirjutage eesmärgid üles
- Pikaajalised (Lisa, miks Zinzinoga tegelete)
- Lühiajalised (Fast Starti boonused ja Zinzino4Free)
Koostage plaan
- Mitu tundi olete nõus iga nädal investeerima?
- Arvutage, mitu kohtumist on vaja, et teenida
Fast Starti boonused
Tutvuge torusüsteemiga
- Tutvuge sellega, kuidas kohtumisele kutsuda
- Võtke ühendust - Kutsuge - EsitlegeJätkusuhtlus - Juhendage
Pange graafikusse komplekti avamise kohumine, ergutuskõne ja oma esimene GoCore'i koolitus
- Üks kohtumine nädalas
Investeerige koolitustesse
- Lisage oma kalendrisse meeskonna koolitused
- Ostke oma esimene ürituse pilet
Tegevused:
Tegelege oma kontaktide nimekirjaga
- Tehke 100 kontakti nimekiri
- Valige oma 20 olulisemat kontakti
Mängige läbi kutse esitamine
Leppige kokku 10 esimest kohtumist
17. 18. 19. 20.
Partnerite värbamise torusüsteem ja klientidele toodete müümise süsteem
LEIDKE POTENTSIAALSEID PARTNEREID
ESITLEGE
POTENTSIAALSETELE PARTNERITELE
Potentsiaalsete partnerite otsimine
1 2 3 4 5 6
kontakti loend
LOO KLIENDID
loomine Lühike esitlus Äritegevuse esitlus
Kohtumine otsuse langetamiseks
ESITLEGE KLIENTIDELE
Terviseteemaline pidu Ja Kliendiesitlus
Võtke ühendust potentsiaalse kliendiga Järeltegevus või

KOOLITAGE PARTNEREID
KAHEKORDISTAMINE
7
Esmane koolitus (Get Started)
Meeskonna koolitus
8 9 10
Äritegevuse planeerimise seanss
Riiklikud ja rahvusvahelised üritused
HOOLIGE
Kliendiesitlus Jagage videoid, veebiseminare, blogisid ja FB gruppe
Teise testi tulemus
Kutsuge klient liituma Zinzino4Freega
Paluge oma sponsoril teile meelde tuletada 120 päeva programmi eelised.
• Q-Team
• Registreerige kaks
• Aidake kahel registreerida kaks
• Saavuta X-Team
Tähtaeg:
Tähtaeg:
Tähtaeg:
Tähtaeg:
Me soovitame teil koos oma sponsoriga koostada 120 päevane eesmärkidega plaan
Võtke kindlasti aega, et mõelda selle üle, mida te tahate Zinzino abil saavutada. Lugege läbi selle brošüüri eesmärkide osa ja pange lk 38 kirja oma eesmärkide plaan.
Valige oma partner komplekt
Koostage Z4F Automaatne tellimus
Tehke BalanceTest
Külastage veebisaiti zinzinotest.com ja registreerige BalanceTesti ID
Pange kirja oma 100+ kontakti loend
Alustage 50–100 vestlust, et suhteid luua
(sotsiaalmeedias, nt Facebookis)
Leppige kokku 10 + 10 kohtumist
Installige GoCore rakendus
Ühinege teemaviitega #Teamzinzinoofficial
Liituge oma meeskonna sotsiaalmeediagrupiga
Vaadake esmase koolituse videoid (Get Started)
Tutvuge Zinzino veebisaidiga
Ostke pilet järgmisele üritusele
Back Office'i põhitõed:
– Looge endale Zinzino veebikonto
– Ürituste kalender
– Failiteek
– Tooteteave
– Partnerite hinnakiri
Vaadake Back Office'i tutvustusvideot

Zinzino karjääriastmetel pole piire. Motivatsioon seisneb teie unistuste suuruses ning on Zinzino karjääri loomisel ülioluline. Unistuste jõud viib teid edasi ka rasketel hetkedel, siis kui tulemused ei vasta teie ootustele.
Kui nii juhtub, siis mõtle: „Mis siis, kui saaksin Crowni tasemele?“ või „Mida ma teeksin, kui oleksin Zinzino President?“ Elava kujutlusvõimega nendele küsimustele vastuseid visualiseerides loote endas soovi õnnestuda. Teis tekib nälg tulemuste järgi. Zinzino sooviks on olla ettevõte, mis aitab teil teie unistusi täita. Olge meie partner, kasvage liidriks ja saavutage oma unistused. Miks mitte?
Kui olete tööga panustanud, olete seda kõike väärt! Jah, olete seda väärt! Koostage nimekiri oma unistustest. Olge küll realistlik, aga ärge unustage ka unistuste jõudu. Ilma unistuse jõuta poleks me saavutanud ajaloo suurimaid leiutisi nagu elekter, lennukid, autod, internet või AI tehnoloogia. Nende leiutiste taga olev unistuste jõud on see, mis annab meile tänapäevased vahendid. Ning just unistuste jõud on see, mis teid lõpuks eduni viib.
Unistame ja saavutame oma eesmärke koos!
„Näen oma pilte unes ja maalin oma unenägusid”
Vincent van Gogh

Otsustage, mida soovite oma äriga saavutada. Kas soovite tasuta tooteid, natuke lisaraha uue auto sissemaksuks või täielikku finantsvabadust?
Olenemata sellest, millised eesmärgid teil on, soovitame nende seadmisel lähtuda SMART mudelist.
Eesmärgid on tähtajaga unistused. Kui te neid üles ei kirjuta, planeerite oma ebaõnnestumist.
„Otsusta, mida sa soovid ning mida sa oled valmis selle eest välja käima. Pane paika oma prioriteedid ning hakka tööle“
H. L. Hunt
Sõnastage oma eesmärgid
Spetsiifilised
Mõõdetavad
Atraktiivsed
Realistlikud
Tähtajalised
Enamikul inimestest on soovide ring, mis väljendab nende eesmärke, unistusi ja tulevikulootusi. Samas on nad vastamisi ka sissetulekute ja reaalsuse ringiga. Enamikul juhtudest need kaks ringi omavahel ei kattu. Soovide ring on tavaliselt suur ja sissetuleku ring sellega võrreldes väga väike.
Zinzino pakub teile võimalust oma sissetulekute ringi suurendada nii, et saaksite järjest rohkem oma unistusi ellu viia. Esimene samm sel teel on kirja panna mõned konkreetsed eesmärgid, mida soovite saavutada.
Seejärel tuleb kirja panna ka tegevuste plaan, mis kirjeldab seda, kuidas neid eesmärke saavutada.
„Inimese
kujutlusvõime on tähtsam kui tema teadmised“
Albert Einstein



Soovide ring
Võlast vaba
Uus maja
Uus auto
Varajane pension
Lastega kodus
Heategevus
Reisimine ja vaba aeg
Aeg iseendale
Ettevõtte omanik
Turvatunne

Sissetulekute ring ?
S petsiifilised, M õõdetavad, A traktiivsed, Realistlikud, Tähtajalised
10 asja, mida ma tahan teha, olla, omada või milleks saada:
Kuupäev:
Kuupäev:
Kuupäev:
Kuupäev:
Kuupäev:
Kuupäev:
Kuupäev:
Kuupäev:
Kuupäev: Kuupäev:
Sea eesmärgid 90 päevaste tsüklitega või üritusest ürituseni. Mida täpsemad on eesmärgid, seda kergem on neid planeerida ja saavutada.
Eesmärgid
90 päeva:
1 aasta:
3 aastat:
5 aastat:
Töötan tundi nädalas Zinzinoga, et seda saavutada.
Pere / Vaba aeg
Aeg Esmaspäev Teisipäev Kolmapäev Neljapäev Reede Laupäev Pühapäev 7:00 8:00 9:00 10:00 11:00 12:00 13:00 14:00 15:00 16:00 17:00 18:00 19:00 20:00 21:00 22:00 23:00 00:00
„Edu pole midagi muud,
kui
lihtsate distsipliinide järgimine iga päev“
Jim Rohn
Zinzino partner, kes järgib eduvõtmeid, võib finantsvabaduse saavutada 5–7 aastaga. Millisena te tahate oma 5–7 aasta plaani näha?
Kaasake planeerimisse ka oma partner või sponsor. Millised olid teie ammused unistused, mis on ajaga kuskile kadunud? Teadke oma potentsiaali ja leidke kirg oma unistuste vastu. See hoiab teid keskendununa ja motiveerib teid läbima oma karjääri esimesi faase.
„Loopida nooli lihtsalt vastu seina pole sugugi nii lõbus, kui tabada märklaua keskele.“
Pidage meeles, et harva saate te midagi täiesti tasuta. Oma soovitud tulemuste saavutamiseks peate alati midagi panustama.

Detailse kompensatsiooniplaani leiate aadressilt zinzino.com. Soovitame teil kompensatsiooniplaaniga põhjalikult tutvuda, et oskaksite seda esitleda, selle kohta küsimustele vastata ja sellele tuginedes seada koos uute partneritega motiveerivaid SMARTpõhimõtet järgivaid eesmärke.
Kõik Zinzino komisjonitasud põhinevad toodete müügimahul, mis on kogunenud ühte või enamasse Income Centerisse (IC). Ärikeskus on positsioon võrgustikus, mille saate, kui registreerite end Zinzino sõltumatuks partneriks. Ärikeskuse loomiseks on teil vaja koos oma sponsoriga ennast partneriks registreerida. Registreerimise käigus saate partneri ID ja parooli, mis annavad teile juurdepääsu tervele Zinzino Back Office’i süsteemile.

Kontaktid
Soovitajad Klientide hankimine
Abi alustamisel
Näita ideed
Koostage vähemalt 100 nimest koosnev loend. Alustage kirjutamist inimestest, kes on teile kõige lähemad. Need on inimesed, keda tunnete, usaldate ja kes teile meeldivad. Enamasti tunnevad nad teie vastu sama. Tihti on nad ka inimesed, kellega sooviksite koostööd teha, sest olete nad ju endale sõpradeks valinud. Teie esimesed tulemused ongi enamasti just sellest nimekirjast tulnud.
Edasi võite nimekirja laiendada kontaktidega, keda tunnete näiteks töö, kooli või mõne organisatsiooni kaudu.
Nimekirja pikendamiseks on väga kasulikud ka tuttavad, kelle leiate oma praeguste kontaktide kaudu. Nimede kirjapaneku peamiseks eesmärgiks on ajurünnaku korraldamine oma olemasolevatele kontaktidele. Selle tulemusena on teil nimekiri, millega tööle hakata ning mille abil hakata uute klientide ning partnerite leidmiseks kontakte looma.
Kui teil on nimekiri valmis, valige sealt välja 10 potentsiaalset klienti ning 10 potentsiaalset partnerit.
Kui jääte jänni oma nimekirja koostamisega, kasutage allolevat loendit inspiratsiooniks või leidke oma sotsiaalmeediast kontakte.
Abiõpetaja
Administraator
Aednik
Aeroobikatreener
Ajakirjanik
Antiigimüüja
Arhitekt
Arst
Arvutiinsener
Automüüja
Bussijuht
Disainer
Elektrik
Esmatarbekaupade pood
Ettekandja
Ettevõtja
Finantsspetsialist
Fotomodell
Geoloog
Golfimängija
Günekoloog
Hambaarst
Hambakirurg
Hotelli juhataja
Isiklik assistent
Jalgpallur
Jurist
Juuksur
Juustumüüja
Katusepanija
Keevitaja
Kindlustusnõustaja
Kingsepp
Kiropraktik
Kirurg
Kodune päevahoid
Kontori juhataja
Kraanajuht
Laborant
Lasteaia kasvataja
Lehekandja
Lilleseadja
Loomapidaja
Läbirääkija
Massöör
Meediakonsultant
Mehaanik
Misjonär
Mustkunstnik
Muusik
Muusikaõpetaja
Muusikaprodutsent
Müürsepp
Mööblimüüja
Nõelraviarst
Omanik
Õmbleja
Õpetaja
Õpilane
Optik
Personaaltreener
Piloot
Poeomanik
Poliitik
Põrandapanija
Postiljon
Preester / pastor
Professor
Psühholoog
Puusepp
Raamatukoguhoidja
Raamatupoe omanik
Refleksoloog
Rekkajuht
Reporter
Restauraator
Sekretär
Sisekujundaja
Sotsiaaltöötaja
Sporditreener
Stjuardess
Taksojuht
Talunik
Tantsustuudio
Teadlane
Tegevusterapeut
Toimetaja
Tuletõrjuja
Turvamees
Tööstustööline
Ujumisõpetaja
Veterinaar
Ürituste korraldaja
Nimi
Partner
Nimi Klient Partner
Klient Partner
Nimi Klient Partner
Nimi Klient Partner

• Osalege koolitusseanssidel ja töötubades
• Vaadake zinzino.tv videoid
• Tutvuge toodete sihtlehtedega saidil zinzino.com
• Lugege veebipoes iga toote infolehte
• Lugege teemakohaseid raamatuid
• Kasutage oma toetusliine
Balance Concept
Balance kontseptsioon
BalanceTest
Health Protocol
Tervise protokoll
Tähelepanu! Toodete saadavus oleneb turust.



Lisaks meeskonna loomisele on oluline laiendada ka oma kliendibaasi. Oma sissetuleku teenite te toodete müügilt. Ütleme, et teie organisatsioonis on 100 partnerit ja igaühel neist on vähemalt 5 klienti. See tähendab, et teie kliendibaasis on 500 inimest. Meie kutsume seda T-tasakaaluks. Klientide / partnerite koguarv. Võime uhkusega öelda, et oleme ühed oma ala parimad, kui asi puutub klientide arvu ühe partneri kohta. See on meile väga oluline väärtus. Veenduge, et oleksite klientide leidmisel ise eeskuju, kes mõistab klientide leidmise tähtsust.
Olge ise parim klient
On tähtis, et viiksite end Zinzino toodetega kurssi. Teie enda kogemus (miks need tooted teile meeldivad) on teie parim müüginipp. Kui te tunnete meie tooteid, tunnete end potentsiaalsetele klientidele ja partneritele neid tooteid tutvustades ja esitledes mugavalt. Kõige paremini müüv lugu on teie enda lugu.
On üsna loomulik, et teie pereliikmed saavad teie kliendiks. Meie esimesteks klientideks on tavaliselt meie pere ja lähim sõpruskond. Meie kutsume seda n-ö soojaks turuks.
Mõelge põhjalikult. Kes teie lähikonnas räägib palju trenni tegemisest? Kellele meeldib tervise eest hoolitseda? Kes on heas vormis? Kes jälgib oma toitumist? Nemad on tihtipeale teie parimad potentsiaalsed kliendid.
Enne, kui asute inimesi kutsuma, soovitame lugeda „5 sammu eduka kutseni“.
Saage oma toetusmeeskonnalt esimesteks esitlusteks abi ja vaadake jaotises „Õppige tundma tooteid“ olevaid videoid ning tutvuge meie toodete sihtlehtedega zinzino.com lehel. Keskmiselt tuleb esimese nelja kliendi leidmiseks esitleda tooteid 10–15 inimesele. Alustage oma parimate potentsiaalsete klientidega.
Valige parim viis potentsiaalse kliendiga ühenduse võtmiseks. Kõik, mis tuleb südamest, mõjub loomulikuna. Te teete seda, mis on teile omane. Pärast aastakümneid otsemüügiga tegelemist oleme leidnud valemi (järgnevatel lehekülgedel), mis töötab kõige paremini, kui hakkate inimesi tooteesitlustele kutsuma. Kui alles alustate inimeste kutsumist, tekib teil tihti tahtmine kõigepealt öelda, miks te nendega ühendust võtsite ning seda veel enne, kui lepite nendega kokku aja toote / ärivõimaluse tutvustamiseks.
Oleme aga otsustanud, et kõigepealt tuleb kokku leppida aeg ja koht –seda põhjusel, et enamik partnereid on esialgselt sellele keskendudes edukamad. Kokkusaamine enne põhjuse avaldamist. Nii ei tule teil koheselt vastata kõigile võimalikele küsimustele, mis on parem suunata kokkulepitud ajal oma sponsorile, kes tuleb kohtumisele koos teiega.
Järgmistel lehekülgedel käime läbi erinevad viisid, kuidas klientide ja parteritega kohtumisi kokku leppida. 5 sammu, mis viivad edukate kutseteni, on alati samad, hoolimata sellest, milliseid tooteid esitlete või kas kavatsete äri tutvustada potentsiaalsele partnerile. Erinevaid kutseid eristab kutsumise põhjus. Harjutamine teeb meistriks ning pärast paari korda muutub see teile loomulikuks ja igapäevaseks.
Saatke sõnum, kirjutage Messengeris või WhatsAppis
Jätke video- või häälsõnum
Saatke teavet ja korraldage kohtumine
1
Sissejuhatus / lobisemine: „Tere, olen „teie nimi“. Kuidas läheb?“
2
Leppige kokku aeg ja koht: „Milline su sellenädala graafik on? Kas saaksime kohtuda esmaspäeval või kolmapäeval?“
3
Põhjus, miks soovite kohtuda: „Soovin sinuga kohtuda, et rääkida: Tervisest / ärist“ (Vaadake järgmistelt lehekülgedelt erinevaid näiteid.)
4
Öelge, et tulete koos oma sponsori / sõbra / kolleegiga ja vastake võimalikele küsimustele: „Tulen koos oma töökaaslasest sõbraga.“
5
Kohtumise kinnitamine: „Kohtume esmaspäeval kell 20:00 (kohtumispaigas)!“
Kui soovite kontakteeruda kellegagi, keda te pole kaua näinud, võib telefoni teel kohtumisele kutsumine tunduda ebaloomulik. Üks võimalus on „alustada“ mõnede inimestega vestlust näiteks tekstisõnumi või sotsiaalmeedia kaudu. Sellise vestluse peamine eesmärk on mõne aja pärast aru saada, millistest teie kontaktidest võiks saada klient, partner või sõber. Üks näide võimalikust dialoogist on järgmine:
1. samm: Teie
„Sattusin sinu Facebooki profiili peale. Kuidas läheb?“
2. samm: Teie
„Millega sa praegu tegeled? / Mille kallal praegu töötad?“
Saage teada, millega teie kontakt tegeleb, kus ta töötab ja millele saate vestluse arenedes keskenduda. Iga inimene on erinev. Mõned igatsevad rohkem vaba aega, sest neil on oma töö juures väga kiire. Teisi huvitab aga oma karjäär, iseenda bossiks olemine, rohkema aja saamine oma pere jaoks, teiste aitamine või meeskonna ülesehitamine. Ehk on neil mingi eriline hobi, nad on mõnes vabatahtlike organisatsioonis või nad on lihtsalt tervisele ja treeningutele keskendunud. Mõte on selles, et oma kontakte veidi paremini tundma õppida ning aru saada, kas tegu on potentsiaalse kliendi, partneri või sõbraga. Leida millega võiks edaspidistes vestlustes nende tähelepanu äratada.
3. samm: Teie
„On sul sel nädalal aega minuga lõunatada / kohvi juua? Kas ma võin sulle homme helistada?“
või:
„Lähen otse asja juurde: Ma ehitan praegu sinu piirkonnas oma äri üles ja otsin just sinusuguseid ambitsioonikaid inimesi. Kui sulle sobib sel nädalal, siis ma tahaksin hea meelega sinuga lõunalauas või tassikese kohvi taga kohtuda, sellega ei kaasne mingeid kohustusi. Kas võin sulle täna hiljem helistada?“
või:
„Üks hea sõber tegi mulle just hiljuti ühe tervisealase väljakutse ja ma tahaks sulle sama väljakutse esitada! Kas võin sulle täna õhtul helistada?“
4. samm:
Helistage ja leppige kokku kohtumise aeg ja koht. Pea meeles põhimõtet, et vähem on rohkem. Asja mõte on leppida telefoni teel kokku kohtumise aeg ja koht, mitte neile kõike ära rääkida.
Me soovitame küll igas oma sõnumis olla personaalne, kuid samas ei tohiks sellele väga palju aega kulutada, sest nii on oht, et ei jõuagi asja tuumani. Ideaaljuhul kasutage eelmisel lehel toodud näiteid, kuid muutke need kindlasti personaalseks vastavalt sellele, kellega räägite. Pidage meeles ka seda, et eesmärk ei ole sõnumi või sotsiaalmeedia kaudu kohtumise aega ja kohta kokku leppida, vaid vestlust alustada ja vanu kontakte „üles soojendada“, et nendega hiljem telefoni teel kohtumist kokku leppida. Soovime edu!


„Oluline pole mitte see, mida sa tead, vaid see, keda sa tead ja keda nemad teavad“
1. samm: Tutvustus
„Tere, olen „teie nimi“. Kuidas sul läheb?“
(Lobisemine)
2. samm: Leppige kokku aeg ja koht
„Kas saaksime kohtuda (päev) või (päev)?“
3. samm: Rääkige põhjusest, miks te tahate kohtuda
Näide 1:
„Mulle esitati mõni aeg tagasi väljakutse muuta oma toitumist ja elustiili ja ma tahaksin sulle sama väljakutse esitada. Räägin sulle rohkem, kui kokku saame!“
Näide 2:
„Mäletan, et kui me viimati rääkisime , mainisid sa oma uusaastalubadust – tahtsid paremasse vormi saada ja vähem suhkrut tarbida. Kuidas sellega läheb?”
„Põhjus, miks ma seda küsin, on see, et ma kasutan toodet, mis aitab mul pärast treeningut varasemast palju kiiremini taastuda ja vähendab mu magusa isusid.“
„Tahtsin sinult küsida, kas tahaksid sellest rohkem kuulda?“
Võite mitte-paksus kirjas lauseosasid muuta, et need oleksid personaalsemad / teile omasemad, jättes paksus kirjas osad muutmata.
Näide 3:
„Kui ma õigesti mäletan, siis oled alati olnud trennile pühendunud ja tervislikult söönud. Ma tahan sulle seetõttu ühe ettepaneku teha, mis võib just sulle sobida. Räägin sulle lähemalt, kui kokku saame!“
Näide 4:
„Põhjus, miks ma sinuga kohtuda tahan, on see, et tahan sulle näidata ühte ainulaadset tervisetoodet, mis koos testiga tõestab ka toote toimet ja annab vastuse selle kohta, kuidas just sinu toitumine su tervist mõjutab.“
Näide 5:
„Ma tean, et oled huvitatud enda eest hoolitsemisest.“
Ma usun, et sa oled juba oomega-3-rasvhappest kuulnud. Ehk oled sa ka oomega-6-rasvhappest kuulnud. Oomega-6 on peamiselt taimne rasv ja oomega-3 leidub kõige enam rasvases kalas. Tänapäeva probleem aga on selles, et inimesed söövad liiga palju oomega-6rasvhappeid ja liiga vähe oomega-3-rasvhappeid.
„Ma alustasin just hiljuti tööd ühe tootega, mis aitab saavutada algupärast rasvhapete tasakaalu nii nagu meie rakkudes peakski olema. Ma räägin sulle lähemalt, kui kohtume ja luban sulle, et asi on tõeliselt huvitav.“
4. samm: Öelge, et tulete koos oma sponsori / kolleegi / sõbraga
„Kuna asusin sellega alles tegelema, võtan endaga kaasa kolleegi / sõbra, kellega koos töötan. Tema teab toodetest rohkem.“
5. samm: Kinnitage kohtumine
„Kohtume siis esmaspäeva õhtul kell 19:00 sinu juures! Ootan põnevusega meie kohtumist, et sulle rohkem rääkida.“
1 „Millega on tegu?“
„Kõigepealt sooviksin kokku leppida aja, et saaksin sinuga täpsemalt rääkida. Kuna näost-näkku kohtumine on praegu veidi keeruline, saame veebis rääkida. Kas see sobiks?“
2 „Räägi lähemalt“
„Meie ettevõte tegeleb analüüsipõhise toitumisega. Kas oled mõõtnud seda, kuidas mõjutab söödava toidu toiteväärtus sinu organismi? Räägin sulle kõigest, kui veebis kohtume. Kas sobib, kui kohtume homme kell 13:00?” (Kui te pole veel kohtumist kokku leppinud, siis võite ka küsida: milline aeg sulle rohkem sobib, kas X või X?)
3 „Ma tean, et söön juba praegu tervislikult...“
„Tore! Ma sooviksin ikkagi sinuga kohtuda, et näidata, kuidas test toimib ja meie tooteid tutvustada. Sellega ei kaasne sulle mitte mingeid kohustusi!“
4 „Kuidas test toimib?”
„See on lihtne kodune test, mis võtab mõned minutid aega. Ma näitan sulle, kui me kohtume.“
5 „Kui palju see maksab?“
„Meil on erinevaid pakkumisi. Ma räägin sulle neist, kui me kohtume.“
6 „Millisest tootest on jutt?“
„See on supertoidulisand, mida saad võtta õlina, vees lahustuva õli kujul või kapslitena. Toon sulle tootenäidiseid, et saaksid neid proovida.“
7 „Kas oled neid tooteid kasutades ise tulemusi näinud?“
Öelge alustuseks ka (rääkige oma testitulemustest, kui soovite)
„Parim osa on see, et kõik saavad toote toimimise kohta tänu testile ise vajalikud tõendid. Selles seisnebki meie ainulaadsus!
Sinu esimene test näitab sulle, milline su tasakaal praegu on.
Meie teine test pärast 120 päeva näitab sulle kõiki muudatusi, mis on tänu tootele juhtunud. Teisisõnu ei pea sa arvama, kas toode töötab või mitte. Me lihtsalt tõestame seda.“
Kirjutage stsenaarium valmis
1. Sissejuhatus / lobisemine:
2. Leppige kokku aeg ja koht:
3. Põhjus, miks soovite kohtuda:
4. Mainige, et võtate kaasa oma sponsori / kolleegi / sõbra ja vastate küsimustele:
5. Kinnitage kohtumine:
Näide 1:
„Kas oled (päev) vaba?
Kas sa tead, et ma hakkasin tervisetooteid turustama? Tahan mõned oma tuttavad enda juurde kutsuda, et teavet jagada ja mõnda tootenäidist proovida. See on mitteformaalne üritus. Mul on sõber / partner / kolleeg samuti kaasas, kel on nende toodetega juba rohkem kogemusi. Võid vabalt naise / mehe / partneri / sõbra kaasa võtta.“
Näide 2: (Keskendu ühele tootele)
Alustasin just enda ettevõttega ja korraldan enda juures neljapäeval 18:00–19:00 esitluspeo. Kas saaksid tulla?
Kinnitage kokkulepe:
„Näeme siis (päev) kell (kellaaeg)
Palun tule õigel ajal. Ootan juba sinuga kohtumist!“

„Oled sa kuulnud Zinzino BalanceTestist?“
„See on test, mis näitab ära, kui hea su toitumine on. Ma kutsun paar tuttavat enda juurde, et näidata toodet, mida olen kasutanud 120 päeva ning saavutanud suurepäraseid tulemusi. Ma tean, et sa oled huvitatud oma tervise hoidmisest ja sooviksin sulle näidata, kuidas see töötab.“
Näide 1:
„Kas oled esmaspäeval kell 20:00 vaba?“
„Ma tean, et sa hoolid oma tervisest ning soovitan sul vaadata sel ajal Facebookis otseülekannet ühelt tervisealaselt esitluselt. Esitluse teeb minu kolleeg / ekspert, kellel on sellekohane kogemus (siinkohal mainige nende kogemust) ning ta räägib, kuidas testipõhised toidulisandid, millega töötan, võivad su tervist parandada. Kas sobib, kui lisan sind üritusele / gruppi?“
Näide 2:
„Kas oled esmaspäeval kell 20:00 vaba?“
„Tunnen huvi sellepärast, et tahaksin sulle näidata paari tervisetoodet, mida olen ise juba mõnda aega kasutanud ja millest on mulle päris palju kasu olnud. Esmaspäeval toimub Facebook Live’is esitlus meie testipõhise toitumise ideest.“
Näide 3:
„Kas oled esmaspäeval kell 20:00 vaba?“
„Teeme Facebook Live'is esitluse meie testipõhise toitumise ideest ja tahaksin selle kohta sinu arvamust kuulda. On sul ehk pool tundi, et sellele pilk peale visata? Kas sobib, kui lisan sind üritusele / gruppi?“
Valige ise, kas suhelda telefoni, sõnumi, sotsiaalmeedia või WhatsAppi teel. Mõningatel juhtudel soovitame kutse edastada mitmel korral erinevate sõnumite kaudu. Soovitame teil koheselt leppida kokku ka uus aeg, et pärast esitlust uuesti ühendust võtta. Kui olete kokku leppinud, et räägite uuesti 30–60 minuti jooksul pärast esitlust, suureneb võimalus, et teie kontakt logib sisse ja pöörab esitlusele rohkem tähelepanu.
Pea meeles:
– Küsige inimeselt üritusele / gruppi lisamise kohta alati luba.
– Kui kutsute inimese üritusele, juhatage ta vajutama „Osalen“ nuppu.
– Kui kutsute inimest grupiga ühinema, selgitage, et kutsele on vajalik vastata, et videole ja grupi teabele ligi pääseda.
– Võtke oma külalisega varem samal päeval ühendust, et talle üritust meelde tuletada.
Meie jaoks on Facebooki Live’i ürituse või Live Zoomi esitluse ettevalmistamine ürituse eelne töö. See tähendab iga nädal ühe tunni leidmist, et inimesi osalema kutsuda ja organiseerida, et kogu meeskond töötaks iganädalase ürituse toimumise nimel. Võite kutsuda ka oma meeskonna 5–6 päeva varem Zoomi koosolekule, et rääkida inimeste üritusele kutsumise protsessist ning paluda kõigil panustada kindla arvu inimeste kutsumisele. Mida paremini teete ürituse eelset tööd, seda paremad on tulemused.
Kuidas tooteid müüa
Läbime alati 5-sammulise müügiprotsessi. Järgnevatel lehekülgedel toome teile esmalt näite ja selgitame, kuidas hõlpsasti korraldada edukas Balance’i toodete esitlus.
Kui olete uus partner, peaksite keskenduma ainult ühele asjale korraga.
Harjutades Balance’i esitlust, arendate oma esitlusoskusi. Me soovitame teil kogu saadavalolev materjal läbi lugeda ning tutvuda ka meie koolitusvideotega internetis. Pidage meeles, et parim viis õppimiseks on praktika, seega hakake juba täna pihta!

1 Tutvustus: Rääkige enda lugu. Meile ei meeldi, kui meile müüakse, aga meile meeldib osta. Seega tuleb kliendi tähelepanu saavutamiseks rääkida, miks sulle toode meeldib ja miks sa otsustasid seda toodet kasutama hakata. Küsige endalt, mis teile toodete juures kõige rohkem meeldib ja miks te tahate sellest teistele rääkida.
2 Kliendi vajaduste väljaselgitamine: Me soovime teada saada oma kliendi huvid. Selleks, et teada saada, kas meie potentsiaalne klient meie toodet vajab, on tähtis, et ta räägiks oma vajadustest.
3 Toote esitlus: Tutvustage toodet ja ettevõtet, mis on toodete taga. Usalduse ja soovi toodet osta saavutame läbi toote eeliste ja faktide väljatoomise.
4 Eripakkumine: Me teeme klientidele eripakkumisi sõltuvalt hooaja kampaaniapakkumistest. Tutvustage esmalt täishinda, enne kui näitate allahindlust, mida saate teha. Kliendi vajaduste analüüsi käigus saadud tulemused aitavad teha talle parima pakkumise.
5 Pärast müüki: Teeme alati kindlaks, et klient on aru saanud, milles ta kokku leppis ja et ta on oma otsusega rahul. Rääkige omapoolsetest järgnevatest tegevustest. Õnnelikud kliendid soovitavad toodet edasi ning Zinzino4Free programmi tõttu on enamik kliente rõõmuga nõus sind aitama, et oma toodet tasuta saada.

Meie kontseptsiooni ja erinevate pakutavate toodete kohta täpsema teabe saamiseks vaadake meie toodete sihtlehti.
Ettevalmistus – võtke kaasa:
• BalanceTest
• Teie valik Zinzino tooteid
• Testitulemused, ka enda omad
• Kliendiesitlus
• Lookbook
• Hinnakiri
• Arvuti / Mac / iPad, et videot näidata või veebitellimusi teha
Enne esitlust esitage endale järgmised küsimused: Mis mulle endale toodete juures kõige rohkem meeldib ja miks ma soovin neist oma klientidele rääkida? Võtke kaasa tooted, mida tahate näidata. Vestelge esmalt kliendiga mitteametlikult ning ärge alustage kohe „müügijuttu“. Teave ja harimine on eduka müügi võtmeks.
1. samm: Tutvustus
Esitluse esimeses pooles on oluline, et te keskenduksite teievahelisele vestlusele, suhtele ja sõprusele, mitte toodetele. Meie eesmärgiks on toodete esitlemisega usalduse ja heakskiidu väljateenimine.
Soovitame valmistuda, vaadates eelnevalt jaotises „Tutvuge toodetega” väljatoodud videoid.
Rääkige enda lugu. Meile ei meeldi, kui meile müüakse, aga meile meeldib osta. Selleks, et kliendi tähelepanu köita, rääkige alati sellest, mis teile toodete puhul meeldib ja miks te otsustasite neid kasutama hakata.
2. samm: Selgitage välja oma kliendi vajadused Esitage küsimusi. See on eduka esitluse võti. Teie lugu on küll oluline usalduse võitmiseks, kuid fookus peaks olema kliendi vajaduste väljaselgitamisel, et saaksite teada, millist toodet kliendile pakkuda.
Küsimused, mida võiksite esitada
• „Kas sinu tervis on sulle oluline?“
• „Mida sa tervena püsimiseks teed?“
• „Kas sa teed mingit trenni?“
• „Kas sind huvitavad terviseteemalised küsimused?“
• „Kas sa tarbid mingeid toidulisandeid?“
• „Mis on sinu arvates tänapäevaste terviseprobleemide põhjuseks?“
• „Kas kujutaksid ette, et testid enda oomega-rasvhapete tasakaalu?“
(Oomega-6-rasvhapped ja oomega-3-rasvhapped)
• „Kas sa oleksid huvitatud tootest, kui saaksid tõestada selle toimet testi abil?“
3. samm: Esitlus
Koostasime lühikese vormi, kuidas Back Office'i failiteegist leitava kliendiesitluse käigus toodet esitleda, kuid peamine tähelepanu peaks olema oma kogemuse jagamisel. See on olulisem kui ükski teine lugu.
Märkus: ärge kunagi lubage kliendile midagi, mis pole Zinzino heaks kiidetud väide. Zinzino Balance toodete suurim eelis avaldub nende pikaajalise tarbimisega. Laske ka oma kliendil tooteid maitsta ja näidake alternatiivseid mooduseid nende tarbimiseks.
4. samm: Eripakkumine
Potentsiaalne klient küsib tihti esitluse ajal hinna kohta. Soovitame oodata, kuni olete tooteid esitlenud ning kogu pakkumist selgitanud.
Nii on tähelepanu toodetel.
Pidage meeles esitada jaemüügihinnad enne seda, kui näitate neile soodustusi. Nii tehes annate kliendile infot, kui palju nad säästavad.
Samuti on kliendil sedasi lihtsam mõista toote väärtust.
Tehke kindlaks, millised tooted teie klienti kõige rohkem huvitavad.
Esitage 1. ja 2. testi jaemüügihind. Siis näidake, kui suure soodustuse nad saavad, kui hakkavad Premier-kliendiks. Peale seda ärge öelge midagi ja oodake, et klient saaks oma otsuse langetada.
Tutvustage kindlasti ka „raha tagasi“ garantiid, mis kehtib neile, kelle testitulemus näitab et nende tasakaal on 3:1 või parem. Andke neile
Lookbooki brošüür või jagage meie pakkumise sihtlehte.
Head küsimused
• „Kas kaaluksid testi tegemist?“
• „Mida sooviksid toodete abil saavutada?“
• „Kas soovid toodet tellida?“
Küsimus?
„Ma ei saa seda endale lubada“ või „See on liiga kallis?“
Vastake
„Kas võimalus püsitellimus tasuta saada võiks sulle huvi pakkuda?“
Rääkige kliendile meie Zinzino4Free programmist
Kui kliendil on konkreetsemaid küsimusi toodete toimimise või koostisosade kohta, leiate enamiku vastuseid meie kodulehelt Korduma Kippuvate Küsimuste alt.
Kui potentsiaalne klient ei ole valmis kohe otsust vastu võtma, leppige kokku aeg, millal uuesti räägite. Tegelik küsimus seisneb selles, kas klient on nõus loobuma tootega kaasnevatest eelistest. Soovitage kliendile vähemalt testi soetamist, et teada saada, mida tal tasuks oma toitumises muuta.
5. samm: Pärast müüki
Kui olete oma kliendi registreerinud, teavitage neid järgnevast:
• Tehke kindlaks, et klient on aru saanud, milles ta kokku leppis ja on otsusega rahul.
• Leppige kokku testi tegemise koht ja aeg.
• Rääkige kliendile meie Zinzino4Free programmist.
• Andke neile teada, et seletate testi tulemused neile lahti, kui tulemused saabuvad.
• Andke oma kontaktinfo ja saatke kliendile pärast esitlust tänukiri meili või sõnumiga. Rahulolevad kliendid, kes saavad müügijärgse tähelepanu, soovitavad toodet ka teistele!
Märkused
Teave teie uuele kliendile
• Teavitage neid saatmiskuludest ja tarnest.
• Kas klient soovib ka lisatooteid?
• Võtke kliendiga nädala pärast uuesti ühendust, et veenduda, kas ta hakkas tooteid tarbima ning vajadusel aidake tal aru saada testitulemustest, kui need ilmuvad aadressile zinzinotest.com.
• Tutvustage neile meie soovitajate programmi.
• Lugege lähemalt aadressil zinzino.com
Valige enda jaoks välja 3–4 peamist toote väärtust, mis teid kõnetavad ja kasutage neid oma müügiprotsessis:
• Need maitsevad hästi
• Saan jätkuvalt kõiki teisi asju nautida, mis mulle meeldivad
• Mul on rohkem energiat
• Testi tegemine on julgustav
• Testi tulemused enne ja pärast näitavad, et see toimib
• Zinzino4Free: Saan toote tasuta tänu soovitajate programmile
• Või valige mõni enda variant...


Õige küsimus on võti õige vastuse juurde.
Kui korraldate Zinzino üritust või aitate seda teha oma meeskonnal, olge kohal vähemalt pool tundi enne külaliste saabumist. Veenduge, et teil on käepärast piisav valik erinevaid tooteid.
1. samm: Tutvustus
Võõrustaja: Võõrustaja tervitab kõiki külalisi ja esitleb inimest, kes tootetutvustust läbi viib. Jutustage lühidalt oma lugu. Kuidas teie saite antud toodetest teada, mis teile nende juures meeldib ning kui kaua olete klient olnud või tooteid turustanud.
2. samm: Selgitage välja oma kliendi vajadused
Julgustage dialoogi ja looge mõnus õhustik, kui küsimusi esitate.
3. samm: Esitlus
Soovitame teile kasutada kliendiesitluse slaide, mis on leitavad Back Office'i failiteegis või Zinzino Lookbookis. Mõnele meeldib alustada Balance’i reklaamvideoga ning seejärel minna esitluse juurde ja alles siis jagada oma BalanceTesti tulemusi. Teised alustavad kohe esitlusega ilma videot näitamata. Pärast esitlust on hea mõte lasta kliendil proovida erinevaid BalanceOil+ maitseid, et leida just temale sobiv.
4. samm: Eripakkumine
Valige välja 2–3 head varianti ja esitlege neid. Keskenduge täishinna väljatoomisele enne soodustuste näitamist.
5. samm: Pärast müüki
Vaata lk 92.
Ja mis kõige tähtsam: lõbutsege!
Ürituse ajal
Paluge oma potentsiaalsetel klientidel lehte värskendada, kui üritus algab. Lisage reaktsioon „Meeldib“, „Armastan“ ja kommenteerige nähtut ürituse ajal. See tõstab osalejate silmis ürituse väärtust. Jagage näiteks oma isiklikku kogemust ja testitulemusi, kui ürituse läbiviija seda palub.
Peale üritust
Helistage oma külalistele ja tänage neid, et nad vaatasid
„Mis küsimused sul tekkisid?“
„Räägi oma lugu. Miks oled sina nende toodete pärast põnevil?“
Esitage tähtsaid küsimusi: „Kas sooviksid teha testi? „Millist BalanceOili maitset eelistad?“ Viige registreerimine lõpule või leppige kokku uus kohtumine (isiklikult, telefonis, veebis).
Kui sa ei saa neid kätte
Tänage neid osalemast sõnumi teel ja küsige, millal neil oleks rääkimiseks sobiv aeg.
Kui neil ei õnnestunud esitlust ettenähtud ajal vaadata, küsige, kas nad võiksid leida selleks aega järgmise 48 tunni jooksul ja leppige kokku uus aeg, millal helistada.
Kui osaleja vastab eitavalt
Paluge luba saata talle tootevideo, mis seletab veidi rohkem. Võtke aeg-ajalt uuesti ühendust. Ei on sageli ei lihtsalt käesoleval hetkel.
Pidage meeles, et edu võti seisneb järeltegevuses.


Tavaline eduretsept oma kliendibaasi suurendamiseks Zinzinos on rahulolevate klientide soovitused. Kui teie klient ühel või teisel põhjusel ei saa inimesi peole kutsuda, on heaks alternatiiviks temalt soovitusi küsida, kellega võiksite ise kliendi asemel ühendust võtta. Palume alati klientidel oma tuttavaid 1–2 päeva ette teavitada enne, kui neile helistame. Üks näide võimalikust vestlusest on järgmine:
1. samm: Tutvustus
„Tere, olen „teie nimi“. Olen ____ (sinu kliendi nimi) sõber. Kas ta andis teada, et ma võtan ühendust? Kas teil on hetk aega rääkida?“
2. samm: Põhjus / Selgita välja vajadused
„Ma helistan sest „su kliendi nimi“ mainis, et te avaldasite huvi meie testi tegemise vastu, et välja selgitada, kas teie toitumine on tasakaalus. Meil on uutele klientidele väga head pakkumised. Kas olete huvitatud meie toodete kohta rohkem infot saama?“ Leppige kokku kohtumise aeg ja koht. Vajadusel saatke videolink teabega ning liikuge 3. sammu juurde.
3. samm: Esitlege pakkumist
Esitlege pakkumist, mis lähtuvalt kliendi vajaduste väljaselgitamisest teie arust kliendile kõige enam sobib. Tutvustage alati enne soodushinna välja toomist kõigepealt täishinda.
4. samm: Lõpetamine
Tavaliselt on esitluse tulemuseks üks kolmest variandist:
1 Registreerige klient veebis
2 Leppige kokku aeg, millal veebis või näost näkku kohtuda
3 Leppige mõne päeva pärast kokku aeg edasiseks suhtlemiseks.
See on paras hetk kliendile meelde tuletada varasemas vestluses tehtud pakkumist.
Ärge kobage pimeduses.
Avastage uus standard parema tervise saavutamiseks.
Tehke esimene test baasjoone mõõtmiseks, enne kui alustate personaalse toidulisandikavaga. Tehke järgmine test, et jälgida oma edasiminekut ja saada tõestust, et tooted avaldavad oma mõju.






meie majasisesed uuringu- ja arendusspetsialistid



Hinnatud arstide, teadlaste, uurijate ja juhtivate terviseekspertide kollektiiv.

… ja maailmas esirinnas kuivveretestide tegemisel. Vitas on sõltumatu GMP-s ertifitseeritud keemiliste analüüside labor Norras, Oslos.
Me oleme Zinzino heaolu konsultandid, mitte tervisenõustajad. Üldreegel on, et klient võib ise lugeda oma testitulemusi ja kujundada oma arvamuse. Meie käest küsitakse, mida erinevad testitulemused tähendavad. Juhime kõigepealt tähelepanu sellele, et tulemuste eesmärk EI OLE kliendile diagnoos anda. Tulemuste eesmärk on teavitada klienti sellest, kas tema toitumises on oomega-6- ja oomega-3-rasvhapete vahekord tasakaalus, peaaegu tasakaalus või tasakaalust väljas.
Seda teades on igaühel võimalik vajaduse korral oma toitumist muuta. Meie töö on kinnitada kliendile, et ta saavutab tasakaalu 120 päevaga, kui järgib meie soovituslikku kolmeastmelist programmi:
1 Sööge oomega-3-rasvhapete rikast ja süsivesikuvaest toitu.
See tähendab, et toitumine peaks sisaldama rasvast kala, puuvilju, salateid, juurvilju, pähkleid ja teisi orgaanilisi toitaineid. Püüdke vähendada taimeõlist ja töödeldud või valmistoidust pärit liigse oomega-6-rasvhapete tarbimist.
2 Täiustage oma toitumist meie Balance toodetega, mis sisaldavad oomega-3-rasvhappeid tasakaalustavaid rasvhappeid ja toitaineid.
3 Alustage treeningprogrammi. Liikumine on hea tervise puhul väga oluline faktor.
zinzinotest.com
Testitulemused on leitavad sellelt veebisaidilt. Kindlasti täitke vorm, et saaksite meili, kui testitulemused on valmis. Kui logite oma testikoodiga sisse, leiate oma tasakaalu kohta rohkem informatsiooni. Leheküljelt saate alla laadida ka toitumissoovituste raporti, mis on koostatud just teie testitulemuste põhjal. Soovitame teha teise testi 120 päeva pärast ja võrrelda oma esimest ja teist testi. Nii on lihtne näha erinevusi, mis tänu Zinzino Balance’i toodetele saavutatud on.

Test annab teile märku, mida peate muutma, et täiustatud tasakaal saavutada...
Teie kaitse (rasvhapete profiili väärtus)
See tegur on seotud 5 kõige bioaktiivsema rasvhappe profiiliga teie veres. Näitajad jäävad vahemikku 0–100 ja eesmärk on aidata kliendil teise testiga (120 päeva möödudes) saada tulemuseks 100. See ei näita midagi inimese tervisliku seisundi kohta, vaid kajastab üksnes rasvhapete kaitsetaset.
Oomega 6 (AA) ja oomega 3 (EPA) tasakaal
Oomega-6-rasvhapete (AA) ja oomega-3-rasvhapete (EPA) tasakaal näitab, kas teie profiil on tasakaalust väljas (üle 9:1), osaliselt tasakaalus (9:1 ja 3:1 vahel) või tasakaalus (3:1 või vähem). Kui teie kliendi väärtus on 3:1 või kõrgem, on eesmärgiks toitumist muuta, et saavutada tasakaal 3:1.
Oomega 3 rasvhapete (EPA + DHA) määr
Protsent näitab EPA + DHA oomega-3-rasvhapete määra kogu rasvhapete profiilis. Rakkude peamise ehitusmaterjalina on oomega-3-rasvhapetel mitmeid kasulikke omadusi. EPA-d leidub enim veres, lihastes ja kudedes, samas kui DHA-d leidub palju ajus, spermas ja silmades. Testi aruandes on nende ideaalne näitaja 8% või kõrgem. Euroopa Toiduohutusamet (EFSA) on kinnitanud, et EPA ja DHA aitavad kaasa südame normaalsele talitlusele. Lisaks sellele aitab DHA kaasa normaalse nägemise ja ajufunktsioonide säilimisele.
Rakumembraani voolavuse indeks
See on tasakaal küllastunud rasvade ja oomega-3-rasvhapete (EPA + DHA) vahel. Küllastunud rasvade voolavus on väiksem kui oomega-3-rasvhapetel. Parem tasakaal 4:1 (küllastunud rasvade ja oomega-3-rasvhapete vahel) suurendab rakumembraani voolavust.
Vaimse tugevusega seotud toitumise indeks
See on tasakaal oomega-6 (AA) ja oomega-3 (EPA + DHA) vahel. Merelist päritolu DHA oomega-3-rasvhappe piisav osakaal toitumises aitab kaasa normaalse ajutalitluse tagamisele. Aju on närvisüsteemi juhtimiskeskus. Aju jälgib ja juhib keha reaktsiooni nägemise, kuulmise, haistmise ja maitsmise kaudu saadud teabele.
Arahhidoonhappe (AA) indeks
AA indeks näitab oomega-6-rasvhappe AA mõõdetud väärtust osakaaluna mõõdetud rasvhapete koguhulgast. Hea keskmine AA väärtus jääb vahemikku 6,5–9,5% (optimaalselt 8,3%)


Kui teil oleks võimalus valida inimesi, kellega koos tööd teha, siis kelle te valiksite? Siin on häid kriteeriume 10 partnerkandidaadi järjestamiseks.
Pange tähtsuse järjekorda inimesed...
• kellega tahaksite koos töötada.
• keda tunnete, kes teile meeldivad, keda usaldate ja kellega samastute.
• kes on müügis või turunduses head.
• kellel on pedagoogiline taust, nt õpetajad, treenerid.
• kes on ambitsioonikad ja kellel läheb juba üsna hästi.
• kellel on kogemusi otsemüügi või sotsiaalse turundusega.
• ettevõtjad, kellel juba on oma äri või kes kaaluksid äri alustamist.
Esitlege potentsiaalsele partnerile ideed lühikese esitlusega näost näkku kohtumisel, Zoomi teel või suunates ta oma Zinzino sihtlehele, kus tal on võimalik videoid vaadata. Teie ülesanne on kutsuda partner kohtumisele, tutvustada oma sponsorit või organisatsiooni ülaliini, kes teiega esitluse läbi viib ning rääkida, miks olete otsustanud Zinzinoga koostööd teha ja miks soovite tulevase partneriga koostööd teha.
Esitluse käigus on teie roll kuulata ja oma sponsori / ülaliini pealt töö käigus õppida. Loomulikult on oluline, et olete kohtumisel „kohal“ –naeratate, teete märkmeid ning näitate, et olete oma ärile pühendunud. See on vaid lühike tutvustus ning ei tohiks kaua aega võtta. Pidage meeles, et liiga palju informatsiooni teeb alustada soovivatele inimestele otsustamise keerulisemaks. Laske oma sponsoril / ülaliinil esitlusi läbi viia senikaua kuni oskate neid ise teha.
Megasuundumus
Zinzino nägemus
Business Presentation Äritegevuse esitlus
Kasutage oma sõnu, kuid võtke eeskuju allolevast formaadist. Kutsudes kedagi lühikesele esitlusele on kõige olulisem alustada kohtumise aja ja koha kokku leppimisega. Pidage meeles, et esmaseks eesmärgiks on kohtumise kokku leppimine, mitte idee enese esitlemine. Rääkige lühidalt ja asjakohaselt, olge entusiastlik ning tekitage kuulajas uudishimu ja soovi rohkem teada saada.
1. samm: Tutvustus
„Tere, olen „teie nimi“. Kuidas sul läheb?“ (Lobisemine)
2. samm: Leppige kokku aeg ja koht
• Uurige välja, millal see inimene teiega kohtuda saaks
• Leppige kohtumiseks kokku aeg ja koht
3. samm: Põhjus
Rääkige põhjusest, miks te tahate kohtuda. Näiteks:
• Tahate neile näidata toodet / äriideed, mis on seotud tervisega
• Teil on ühe põneva toote levitamise õigus
• Hakkasite tegelema tervisetööstuses turunduse tööga
• Teil on idee, mida soovite neile näidata
• Tahate nende arvamust seoses ühe äriideega, millega te tegelema hakkasite
• Kutsute neid Facebook Live'i üritusele / gruppi, kus nad saavad rohkem teavet teie äri kohta
4. samm: Vastake võimalikele küsimustele
• Tahan ideed vaid esitleda
• Sellele kulub vaid 30 minutit
• Raske on telefoni teel kõikidest üksikasjadest rääkida, seepärast tahan sinuga näost näkku kohtuda
5. samm: Kinnitage kohtumine
• Paluge oma kontaktil kohtumise aeg kirja panna
• Öelge neile, et võtate sõbra / kolleegi kohtumisele kaasa
Veel nippe
• Korraldage kohtumine oma sõbra lähistel.
• Öelge neile: „Vastan kõikidele su küsimustele, kui me kohtume.“
• Kui see kohtumine on pikalt ette broneeritud, tuletage seda sõnumiga päev varem meelde
• Inimestega, kellega te pole viimasel ajal ühenduses olnud, soovitame dialoogi alustada läbi sotsiaalmeedia või sõnumite. Vaadake sellega seoses jaotist „Avadialoogid“, mille leiate selles brošüüris lk 70.

Alternatiiv 1:
• Mäletan, et kui me viimati rääkisime, mainisid, et sa pole oma tööga eriti rahul ja otsid teisi variante. Kuidas sellega läheb?
• Küsin seepärast, et arendan äri testipõhise toitumise alal / tervise ja toitumise alal / laiendan oma äri piirkonnas, kus sa elad... ja ma tahtsin küsida, kas oled lisainfo saamisele avatud?
Alternatiiv 2:
• Ma helistan, sest ma rajan oma äri tervise ja heaolu alal ja sina tulid mul mõttesse, sest
• tean, et sulle meeldib müügiga tegeleda / tean, et töötad või töötasid tervise alal / tean, et oled mõjukas / tean, et sul on suur tuttavate võrgustik / tean, et oled alati olnud ambitsioonikas ja eesmärkidele pühendunud / tean, et sul on treeneri taust / tean, et sa oskad hästi inimestega suhelda...
• Mul on sulle lihtne küsimus: kas oled avatud uutele võimalustele?
Võite mitte-paksus kirjas lauseosasid muuta, et need personaalsemad / teile omased oleksid, jättes paksus kirjas osad muutmata.


Kirjutage käsikiri, kuidas keegi lühikesele esitlusele kutsuda
1. Sissejuhatus / lobisemine:
2. Leppige kokku aeg ja koht:
3. Põhjus, miks soovite kohtuda:
4. Mainige, et võtate kaasa oma sponsori / kolleegi / sõbra ja vastate küsimustele:
5. Kinnitage kohtumine:
Me kutsume oma süsteemi liinistikuks, sest see sõna sümboliseerib edasiliikumist hoolimata jõupingutustest. Esmalt tuleb arusaada põhimõttest ning kuna harjutamine teeb meistriks, siis soovitame teil iga samm hoolikalt läbi teha.
TEKITAGE POTENTSIAALSEID KLIENTE
Kui näitate üles huvi nende tegevuse vastu, on nad nõus teie tegevusega tutvuma.
Potentsiaalsete partnerite otsimine 100+ kontakti loend
ESITLEGE POTENTSIAALSETELE KLIENTIDELE
Kui inimene tunneb teid, te meeldite talle ning ta usaldab teid, on nad nõus teiega äri ajama.
Kontakti loomine Lühike esitlus
Äritegevuse esitlus
1 2 3 4 5 6
TULEMUS
Kohtumine otsuse langetamiseks
SP
KOOLITAGE PARTNEREID
Tahate parima koolitusega meeskonda maailmas?
Olge juht, keda nad tahaksid järgida.
KAHEKORDISTAMINE Edu saladus.
Esmane koolitus (Get Started) Meeskonna koolitus
SP tähendab meie pakutava ärivõimaluse lühiesitlust (Short Presentation). Kohtumise käigus juhendab teid teie sponsor või ülaliin. Järgmisel leheküljel saate lähemalt lugeda, millele lühiesitluse (SP) käigus keskenduda. 7 8 9 10
Äritegevuse planeerimise seanss
Riiklikud ja rahvusvahelised üritused
SP = Short Presentation (Lühike esitlus)
CP = Customer Presentation (Kliendiesitlus)
ZP = Zinzino party (Zinzino pidu)
BP = Business Presentation (Äritegevuse esitlus)
BPS = Business Planning Session (Äritegevuse planeerimise seanss)
1. Suhete loomine
Kogu otsemüügi valdkond on üles ehitatud suhetele. Seepärast me keskendumegi nii palju isiklikule arengule, juhtimisõpetusele ning inimeste sotsiaalsuse arendamisele. Kui olete inimene, kellega inimesed suhestuda ei saa, on teil raske uusi sõpru leida ning inimestega äri ehitada.
Teie esimene ülesanne esitluse alguses on potentsiaalse partneriga sõbraks saada. Siin pole ühtegi trikki ega tehnikat, kuid see peaks olema aus ja personaalse lähenemisega. See algab kuulamisest, mis on elus üks kõige väärtuslikematest, kuid harva esinevamatest oskustest. Küsige küsimusi ning õppige tundma inimest, kellele äri tutvustama hakkate.
• Mis tööd ta teeb?
• Kas tal on lapsi?
• Mida talle meeldib vabal ajal teha?
• Kas teil on ühiseid huvisid?
Näidake üles oma huvi inimese vastu, kes teie vastas istub. Kuulake ja õppige teda tundma. Esimene ülesanne ongi temaga sõbralik suhe luua.
Et sõbrasuhet luua, on vaja lasta tal ka ennast tundma õppida, et inimene saaks teiega samastuda.
Meeldib see teile või mitte, aga esmamulje määrab suures osas selle, kuidas te inimestele meelde jääte ja seetõttu mõjutab see teie tulemusi. Kuidas te sooviksite, et teid kohvikus koheldaks? Kuidas te sooviksite, et teenindav personal riides oleks ja käituks? Kuidas te sooviksite, et näeks välja kogu töökoht ja letitagune? Jätke hea esmamulje. Riietuge ärile vastavalt, kuid mugavalt, hoolitsege oma hügieeni eest (dušš, puhtad küüned ja hambad, hea lõhn, puhtad riided) ning NAERATAGE suurelt.
Teine ülesanne esitluse käigus on aru saada, mida inimene tahab. Millised on tema eesmärgid ning unistused? Enamikul inimestest on küll pikk soovide nimekiri, mis tihti läheb üle fantaasiateks. Kuid nende unistused on enamasti liiga suured, et nende saavutamiseks piisavalt palju tööd tahta teha. Meie ülesandeks on aru saada, mida täpselt nad saada soovivad. Mille suhtes nad päriselt kirglikud on?
Unistus on sageli miski, mida inimesed oma eluajal saavutada tahavad. Millist soovi saab teie ja Zinzino abil saadud rohkema raha, aja ning isikliku vabaduse abil täita? Mida nad teeksid, kui võidaksid lotoga peavõidu? Mis on nende suurim motivaator?
See võib tunduda keerulisem, kui ta tegelikult on. Enamik inimesi on unistajad. Enamik inimestest unistavad perega rohkem aega veeta, laenusummat vähendada, paremat finantskindlust saavutada, rohkem sõpru ja suuremat sotsiaalvõrgustikku omada, teisisõnu täpselt seda, mida teie äri pakub! Seetõttu on äärmiselt oluline alguses sõbralikku suhet luua, küsimusi küsida ning kuulata. Samal ajal, kui te õpite inimest tundma, leiate ka tema motivaatori. Kui inimesele tundub, et ta teid piisavalt ei tea, ei usalda või kui te talle ei meeldi, siis ta suure tõenäosusega teile ennast ei ava ega räägi, millest ta unistab.
Pidage meeles, et kui teil enda unistusi ei ole, on teil raske ka teiste omi avastada. Hoidke oma unistused elavatena, sest see aitab ka teistel inimestel enda omi leida. Järgmiseks ülesandeks on esitluse käigus aidata inimestel aru saada, mida neil Zinzinoga koostöös on võimalik saavutada. See on väga oluline küsimus, millele nad peaksid vastuse leidma.
3. Edastage positiivsust
Ørjan Sæle kirjutab oma raamatus „90 Days to Win“, et vastavalt uuringutele on müügitulemused mõjutatud vaid 7% meie kasutatud sõnadest, 38% hääletoonist ning 55% kehakeelest. Sel põhjusel on meie positiivsel hoiakul ning käitumisel meie tulemustele tohutu mõju. Kui räägite, et pakute suurepäraseid võimalusi ja usute helgesse tulevikku, siis tahavad inimesed sellest osa saada!
Entusiasmil on väga suur osa tulemuste saavutamisel! Kui projekt tundub tüütu, siis seda ei alustata. Entusiastlik suhtlemine on tähtis nii inimest äri- või kliendiesitlusele kutsudes kui ka kogu edasise protsessi käigus. Pidage meeles, et teie entusiasm peab peegelduma edastatavas sõnumis.
Osadele inimtüüpidele ei ole see mingi probleem. Nad kohtuvad kõigiga lai naeratus näol ja külvavad rõõmu igale poole, kuhu lähevad. Samal ajal teised arvavad, et nad on entusiastlikud, aga kilomeetri raadiuses jäävad kõik igavusest magama. Seega on oluline teada, millisesse kategooriasse te kuulute. Kui teis on liiga palju entusiasmi, on võib olla tark seda veidi maha keerata, et teistel oleks kergem teiega samastuda. Teised aga peaksid seda veidi juurde panema. Pidage meeles, et hoiak ja emotsioon on nakkavad. Kui väljendate mingeid tundeid, siis veenduge, et need tunded on positiivsed!
4. Leppige kokku 2. kohtumine
Üks esitluse kõige olulisemaid osi on järgmise kohtumise kokkuleppimine. Me Zinzinos teame, et 2 / 3 inimestest, kes alustavad äripartneritena, teevad oma otsuse kas 2. kohtumise või äritegevuse esitluse (BP) ajal. Oleme tihti näinud, et partner on teinud väga hea töö inimeste esitlusele kutsumisega. Nad on teinud informatiivse ja entusiastliku esitluse, kuid mingil põhjusel lõpetavad nad kohtumise ilma uut aega kokku leppimata, et potentsiaalse kliendiga edasi suhelda. Ärge seda viga tehke! Ärge kunagi lõpetage kohtumist sõnadega: „Ma helistan sulle“. Ausalt öeldes nii võite nende nime oma nimekirjast kohe maha tõmmata. Tõenäoliselt helistate neile korra või kaks. Olenemata tulemusest olete pannud end olukorda, kus ajate neid uue kohtumise eesmärgil lihtsalt taga.
Aja kokku hoidmiseks, tulemuslikkuse tõstmiseks ja eneseväärikuse säilitamiseks leppige uus kohtumine kohe kokku. Võite uue kohtumise ka kohe esitluse alguses kokku leppida.
„Sinu entusiasm on sinu tulemuste vundament“

Profi nipp!
Pange tähele, milline on teie näoilme, kui olete entusiastlik!
5. Kaasake nad süsteemi
Süsteemis on olemas kõik vajalikud materjalid ja kohtumiste formaadid, mida me kasutame Zinzinos juhtimisoskuste edendamiseks. Kui potentsiaalsed kandidaadid tahavad toodete kohta rohkem teavet, suunake nad klientide veebilehele - jaotise Avasta all. Kui nad tahavad äri kohta rohkem teavet, suunake nad partnerite veebilehele. Kui neil on vaja lisateavet otsemüügi kohta, on hea soovitus neile laenata Robert Kiyosaki raamat: „The Business of the 21st Century“.
Kui nad registreerisid end esitluse ajal partneriks, andke neile käesolev brošüür ja paluge see enne järgmist kohtumist läbi lugeda ning alustada nimekirja koostamisega.
Osalege alati kohalikel või veebis toimuvatel äriesitlustel (BP) ja teie lähistel toimuvatel üritustel. Me soovitame tugevalt uutel partneritel võtta harjumuseks kuulata GoCore rakendust, millele nad saavad ligipääsu, kui neil on Z4F komplekt Auto Orderi tellimuses. Nii saab igaüks konkreetse koolituse, kuidas oma äri rajada. Eelkõige seetõttu, et motiveerimine on nagu duši all käimine. Isegi kui olete seda juba teinud, ei tee paha toimingut korrata. Lisaks võib teil äri kasvades olla keeruline igal pool korraga olla. Kui suunate kõik oma partnerid süsteemi, annate neile võimaluse saavutada edu ja juurdepääsu heale koolitusele.
Teine eelis kõiki äritegevuse esitlustele ja üritustele suunamisel on see, et teie partnerite suhtlusring kasvab. See innustab, sest kohtuvad sarnaselt mõtlevad inimesed, kes püüdlevad sarnaste eesmärkide ja unistuste poole.

Profi nipp!

• Teie lugu
• Kes te olete?
• Kas teil on põhitöö?
• Kuidas te sellega tegelema hakkasite?
• Miks valisite just Zinzino?
Kui kiiresti jätame esmamulje? Vähem kui 30 sekundiga! See mulje inimesest on meil seni, kuni teda paremini tundma õpime. Seetõttu öeldakse: „Teeseldud naeratus on parem kui ehe tõredus.“ Hea esmamulje jätmine on väga tähtis hea lühiesitluse tegemiseks. Naeratage, olge potentsiaalset partnerit tervitades viisakas, hoidke rühti ja kandke korralikke riideid. Südamest tulev siiras naeratus on parim.
Kui olete selles äris alles uus, on hea, kui lasete kellelgi, kes teab süsteemi ja materjali hetkel teist paremini, ennast aidata. See on nagu juhilubade saamine. Algul olete kõrvalsõitja, siis harjutate sõitu õpetaja kõrval.
Pärast seda sõidate omapäi, siis on teil kaassõitjad ja lõpuks saab teist õpetaja, kes aitab teistel sõitma õppida. Seetõttu on meie soovitus, et teil oleks alguses nii äri- kui ka kliendiesitlustel kaasas oma sponsor või keegi ülaliinist.
Kinnitage kohtumine. Olge aegsasti kohal. Kasutage selles brošüüris soovitatud esitlusi ja materjale.
Inimesele, kes esitlust läbi viib: Öelge oma partnerile, kuidas te soovite, et ta kohtumise ajal käituks. Tooge näiteid, kuidas peaks kõlama sissejuhatus. Korjake inimese kohta, kellega kohtute, vajalikku taustainfot.
Partnerile, kes on üritusele kutsunud: Kui kohtumisel on keegi ülaliinist, paluge temalt pärast kohtumist konstruktiivset tagasisidet. Kui õpite igal kohtumisel, mida paremini teha, saavutate oma tulemused kiiremini.
2 Inimesega tutvumine
Lisateavet leiate jaotisest: Nipid lühiesitluse jaoks. Tekitage hea õhustik. Jagage tunnustust ja tehke tutvumise ajal komplimente ning andke inimesele teada, miks te just teda kohtumisele kutsusite.
Milline on teie lugu? Mis Zinzino juures teid motiveeris, mida nüüd teistega jagate?
Motiveerivad asjaolud
• Lisasissetulek
• Teiste aitamine
• Finantsvabadus
• Varajane pension
• Tooted
• Isiklik areng
• Uus karjäär
• Sotsiaalne aspekt
• Oma äri alustamine
Esitluse käigus on kõige kergem rääkida just nendest asjadest, mis teid kõige enam motiveerivad. Esitluse tulemus aga oleneb siiski kõige rohkem sellest, kas leiate üles kohtumisele tulnud inimese vajadused ja motivatsiooni.
Sissejuhatus: Võib juhtuda, et alustate esitlust iga kord erinevalt. Püüdke seda vältida.
On parem ja dubleeritavam alustada esitlust iga kord ühtemoodi. Hea avalause loob mugava õhustiku ning äratab edasise vastu huvi.
Meie äri on üles ehitatud teiste aitamisele. Läbi selle saame edukaks.
Esitlus: Esitlema õppimine algab hetkest, mil te lepite kokku oma esimese kohtumise. Alguses aitab teid sponsor või teie ülaliin, kuid lõpuks tunnete protsessi ise piisavalt hästi ja saate seda korrata ning ise oma tiimi aidata. Oluline on alustada ja mitte oodata, kuni kõik on selge. Harjutamine teeb meistriks.
Lõpetamine: Kas sooviksid tasuta tooteid või kaaluksid koos meiega äri rajamist, et luua endale sissetulek?
Üks lähenemine oma loo arendamisele võiks olla järgmine (täida lüngad oma käsikirjas)
• Nagu sa tead / võib-olla ei tea... Ma olen...
• Ja ma armastan / vihkan seda, sest...
• Probleem on selles, et...
• Nii et hakkasin vabal ajal kodust selle äriga tegelema, et... X kuu / aasta pärast saaksin...
• Tahan seda sinuga sellepärast jagada, et... (põhjus, miks valisite oma potentsiaalse kandidaadi ärivõimaluse tutvustamiseks).


Pange kirja oma isiklik lugu
1. Teie lugu:
2. Kes te olete?
3. Kas teil on põhitöö?
4. Kuidas te sellega tegelema hakkasite?
5. Miks valisite just Zinzino?
Head küsimused esitluse lõpetamiseks:
• Mida pidasid Zinzino, toodete või ärimudeli juures kõige põnevamaks?
• Kas tahaksid testi teha ja tooteid proovida?
• Kui hakkaksid sellega tegelema osalise / täisajaga, kui palju raha peaksid kuus teenima, et see äri oleks väärt su aega?
• Kui võiksin sulle näidata plaani ja süsteemi, kuidas saavutada „1000 eurone“ igakuine sissetulek osalise või täisajaga töötades, kas sul oleks vaja veel midagi teada enne alustamist?
• Arvan, et meil võiks hästi minna. Kas tahaksid meiega koos äri ajada?
• Kas su eelarvele sobiks täna alustada Ultimate Partner Kitiga?
Küsige kindlasti kõige olulisem küsimus:
• Kas sul on soov alustada minuga / meiega koostööd?
Järeltegevus
Iga kohtumine peaks alati viima järgmiseni. Võtke välja oma kalender ja pange paika, kuidas ja millal uuesti kokku saate. Kohtumise sisu sõltub sellest, mida teie külaline vajab. Kas tal on vaja kliendiesitlust (CP),
2. kohtumine, esmast koolitust (Get Started), äritegevuse esitlust (BP) või Zoomi /Facebook Live'i üritust? Te ei pea ootama, et klient otsustaks, järgige lihtsalt samm-sammult süsteemi liinistikku.
2. kohtumine
See on jätkukohtumine, mis tuleks korraldada 48 jooksul pärast potentsiaalse partneriga kohtumist. Selle kohtumise käigus saavad nad vastused kõigile küsimustele kas kliendiks olemise või ärivõimaluse kohta. Kui teil oli kliendiesitlus, kus potentsiaalne klient ei teinud veel lõplikku otsust, soovitame temaga kas telefonikõne või sõnumi teel uuesti ühendust võtta.
• Vastake küsimustele, mis on teie potentsiaalsele partnerile olulised.
• Mis teie potentsiaalset partnerit motiveerib?
• Kas nad said kompensatsiooniplaanist aru?
• Kas nad said Zinzino süsteemist aru?
• Kas nad said aru toodete potentsiaalist ja ajastusest?
• Käige läbi 120 päeva eesmärgid ning eelised boonustele kvalifitseerumiseks.
• Lisasissetulek
• Teiste aitamine
• Finantsvabadus
• Varajane pension
• Tooted
• Uus karjäär
• Isiklik areng
• Sotsiaalne aspekt
• Oma äri alustamine

Kodused kohtumised – offline või online
Neid kohtumisi korraldavad erinevad meeskonnad kas korra või mitu korda kuus. Eesmärk on anda potentsiaalsetele partneritele, kes on osalenud lühiesitlusel (SP), rohkem teavet ärivõimaluse kohta. Pärast kohtumise informatiivset osa koolitatakse osalejaid Team Zinzino süsteemis. Neid kohtumisi saab korraldada ka veebis Zoomi vahendusel või kohalikes Facebooki gruppides.
Äritegevuse esitlus – offline või online
Neid korraldatakse iga nädal või igal teisel / neljandal nädalal olenevalt sellest, kus te elate ja millise meeskonna osa olete. See on koht, kus potentsiaalsed partnerid, kes on osalenud lühiesitlusel, saavad rohkem teavet ning teie meeskond saab neid koolitada. Äriesitlused on üpris sarnased sõltumata sellest, millises linnas neid korraldatakse. Sel viisil saate olla alati kindel, et teie partnerid on korrektselt informeeritud ja kõik järgivad sama süsteemi. Offline korraldatud kohtumisel on kaks osa, millest esimene on informatiivne, kus räägitakse ärist ja teine hõlmab koolitust. Online kohtumine toimub Zoomi või kohalike gruppide kaudu Facebookis. Kutsuge potentsiaalsed partnerid osalema ja käige ka ise regulaarselt kohal, kui soovite rajada suurt äri.
Meeskonna koolitus
Koolitus grupile, mis pakub teie ülaliin– online või silmast silma.
Äritegevuse planeerimise seanss – BPS
Korraldatakse kohalike, riigisiseste ja rahvusvaheliste ürituste vahepeal. Need kestavad kuni neli tundi ning keskenduvad erinevatele teemadele, mis pannakse kokku vastavalt kohaliku organisatsiooni vajadustele.
Üritus
Ühe- või mitmepäevaste ürituste käigus antakse sulle motivatsiooni ja teadmisi selle kohta, kuidas oma eesmärke saavutada. Zinzino pakub virtuaalseid ja silmast silma üritusi ja rahvusvaheline Annual Event on iga aasta tähtsündmuseks.
Zinzino meeskond kasutab 5% oma ajast üritustel osalemiseks ning suurte ürituste turustamiseks oma tiimile. Suurepäraste kõnelejatega üritusel osalemine mõjub fantastiliselt. Tooge oma meeskond järgmisele suurele üritusele. Nad saavad sellest uskumatu motivatsioonilaengu. See motivatsioon kajastub tihtipeale koheselt ka tulemustes. Me näeme, kuidas selline väike ajaline investeering võib äris anda kuni 80% tulemustest. Ürituste ajal sünnivad unistused ja võetakse vastu otsused ärile pühenduda.
Seega ärge jääge järgmisest üritusest ilma. Ärge unustage ka reklaamida kõiki põnevaid kampaaniaid, mida Zinzino korraldab, enne ja pärast üritusi.
Tutvuge ürituste kalendriga Zinzino Back Office'is ja lisage kuupäevad oma märkmikusse.


1 Anna teada ürituse toimumise aeg ja koht. Laske oma tiimil see enda kalendrisse panna, et aeg oleks broneeritud ja miski ei saaks vahele tulla.
2 Selgitage, miks on üritusel osalemine oluline. Mis on teemaks? Kes on peakõneleja? On oluline, et oleksite oma meeskonna jaoks olemas. Saate sealt vajalikud teadmised. See on kohustuslik, kui tahate suurt edu saavutada.
3 Üritust reklaamides on oluline jagada emotsiooni. On oluline mõista, et kui me reklaamime ilma põhjust välja toomata, siis võib see kergesti tunduda ülepaisutatud ja liialdatud üritusena. Mida paremad reklaamijad oleme, seda rohkem inimesi tahab üritusele tulla.
4 Müüge pileteid. Kui inimene ei saa koheselt maksta, organiseerige, kuidas ja millal saaks inimene oma pileti tellida.
Teie grupp pole suurem tiimiliikmetest, kes üritustel osalevad
Üks olulisemaid mõõdetavaid tulemusi nägemaks, kuidas teie grupp kasvab, on jälgida, kuidas osalejate arv üritustel suureneb. See grupp inimesi, kes üritustel osaleb, on teie tuumik. Üritustel saame vajaliku informatsiooni, inspiratsiooni ning usu edasiminekuks. Soovitame ka ürituste vahel oma eesmärke seada.
Oma meeskonna ülesehitamise käigus puutute kokku väga paljude küsimustega. Pidage meeles, et see on täiesti normaalne ja kui te meenutate aega, mil te veel partner ei olnud, siis kindlasti olid mõned neist küsimustest ka teil mõttes. Tehke vahet küsimusel, vastuväitel ja vabandusel. Vastuväide on hea küsimus, millele vastates aitame inimesel otsusele jõuda.
Vabandus toob aga tavaliselt pärast sellele vastamist uusi vabandusi. Uuringud näitavad, et 90% öeldust on arvamused ja vaid 10% on faktid. Harige end ja õppige arvamustel ja faktidel vahet tegema. Meie kogemus näitab, et vastuväide on tegelikult märk ehedast huvist meie ärimudeli vastu. Vähesed inimesed raiskavad aega küsimaks asja kohta, millest nad huvitatud ei ole. Soovitame teil kasutada oma sponsori abi küsimustele vastamisel.
Iga küsimusega suurendate oma teadmistepagasit järgmine kord vastamiseks. Kasutage võrkturunduse, kompensatsioonimudeli, süsteemi ja toodete kohta teabe saamiseks kõiki olemasolevaid materjale. Saage oma elukutse meistriks. Kui tunnete end mugavalt ja teadlikult, kiirgate enesekindlust ja see avaldub teie esitlustes.


Kas kuulute nende hulka, kes arvavad, et neil on piiratud tutvusringkond? Ärge muretsege! Meil on teile lahendus.
Uute klientide ja partnerite lisandumisel teie ärisse, avaldub eksponentsiaalne efekt. Teie kontaktid tunnevad inimesi, keda teie veel ei tunne jne. Öeldakse, et olete vaid nelja sammu (kontakti) kaugusel inimesest, kellega tahate suhelda. Proovige ise järele! See on uskumatu, aga tõsi. Sotsiaalmeedia kanalid nagu Facebook, X ja teised on maailma nii väikseks teinud ja sellega suurendanud võimalust rohkemate inimestega kontakti luua.
Me õpetame teid, kuidas oma meeskonda aidata. Koos töötamisel on suur jõud ja mõju. Koos oma tiimiga töötades on võimalused lõputud!
1 Naeratage: Rääkige enda lugu. Meile ei meeldi, kui meile müüakse, aga meile meeldib osta. Seega tuleb kliendi tähelepanu saavutamiseks rääkida, miks teile toode meeldib ja miks te otsustasite seda toodet kasutama hakata. Küsige endalt, mis teile toodete juures kõige rohkem meeldib ja miks te tahate sellest teistele rääkida.
2 Igaüks puudutab kedagi: Tegutsemine tähendab tulemusi. See tähendab, et peaksite oma iganädalasi tegevusi planeerima. Soovitame teil aktiivselt töötada keskmiselt 15 tundi nädalas.
3 Igaüks õpetab kedagi – Järgi süsteemi: Kordamine ja meeskonnakaaslased on Zinzino meeskonna süsteemis olulised asjad. On oluline, et osaleksite kõikidel üritustel – alates äriesitlustest kuni kohalike, piirkondlike, riiklike ja rahvusvaheliste üritusteni ning samuti teie meeskonna korraldatud töötubades. Alguses õpetate oma meeskonda, tuues nad kohtumistele, kuid tulevikus võib just teist saada see, kes õpetab kõiki teisi lavalt.

4 Inimeste ühendamine – Ühendage inimesi, 2 päevas:
Me töötame suheldes, mis tähendab, et me ühendame inimesi.
Viies potentsiaalse partneri kokku kellegagi ülaliini meeskonnast, suurendate võimalust, et uus inimene alustab äri loomisega.
Mida rohkem on uuel partneril kontakti oma ülaliiniga, seda kiiremini ta areneb ja edeneb. Tutvustage üksteist meeskonna kohtumistel, telefoni või Zoomi teel või kasutage näost näkku kohtumisi.
5 Õpetatav – 30 minuti iga päev isiklikuks arenguks:
Ilma isikliku arengu plaanita, planeerite te ebaõnnestumist. Eduka äri saladuseks on esmalt iseenda juhtimisoskuste arendamine ning seejärel teiste juhendamine. Teie eesmärgiks peaks alati olema areng ja püüdlemine paremuse poole. Kuulake GoCore'i rakendust ja lugege GoCore'i koolitussüsteemi soovitatud raamatuid.

Eesmärkide saavutamiseks on oluline oma nädalalakava ette planeerida. Soovitame iga nädal veeta 30–60 minutit järgmist nädalat planeerides. Olles mitu päeva ettevalmistunud, saate oma tulemusi paremini kontrollida. Zinzinos on kõige edukamad need, kes keskenduvad järgmisele kolmele põhimõttele:
1 Tegutsemine tähendab tulemusi: Zinzino professionaalina, kes tegeleb äriga osaliselt, peab teil kuus olema vähemalt 15 kohtumist, uut tutvust, et leida potentsiaalseid kliente ja partnereid. Kui tegelete äriga täiskohaga, peaks teie kalendris olema vähemalt 15 kohtumist nädalas.
2 Piletiomanik: Teil peab alati olemas olema pilet järgmisele üritusele või juhtimiskoolitusele.
3 GoCore rakendus: Järgite süsteemi ja kuulate iga kuu GoCore rakendust.
Et see eesmärk saavutada, peab teil olema plaan. Seega keskenduge järgmisele:
• Mis kell te hommikul ärkate?
• Mis kell te voodisse lähete?
• Millised on teie töötunnid oma tavatööl?
• Mida peab tegema selleks, et teie ajakava klapiks teie ja teie pere eluga?
• Millist aega saate kasutada, et arendada oma Zinzino äri?

Pakume teile vajalikku juhendamist, tuge ja koolitusi, et meiega edukat
äri kasvatada. Olgu selleks meie toodete jagamine uute klientidega, uute partnerite leidmine et meie ärivõimalusega liituda, või mõlemat!
Järgige süsteemi, mis on tõestatult edukas
Zinzino partnerina peate keskenduma vaid sellele, milles te osav olete – uute inimestega kohtumisele ja teie kogukonna suurepäraste tootekogemuste jagamisele. Kõige muu eest hoolitseme meie. Teie peamised väärtused on sotsiaalsed oskused ja avatud suhtumine. Te ei pea välja mõtlema parimat moodust töötamiseks. Süsteem on juba paigas. Ühinete ärimudeliga, mis on tõestatult edukas ja põhineb tegevuse käigus õppimisel. Lihtsalt imiteerige ja jäljendage seda, mida on aastakümnete vältel proovitud, katsetatud ja täiustatud. Siis võtke kätte ja õpetage inimestele enda ümber sama asja. See meetod töötab nii veebis kui ka offline'is! Suust suhu liikuv turundus on supervõime, mis võimaldab kõikjal äri ajada. Vaja läheb vaid suurepärast lugu ja õigeid tööriistu selle jagamiseks.
Me toetame teid. Saate oma isikliku veebisaidi, et teie klientide veebikogemus oleks võimalikult personaliseeritud. See on zinzino.com-i jäljendav lehekülg, kus on teie nimi ja mis sisaldab asjakohast kergesti jagatavat sisu meie põhipakkumiste, menukite, toote põhimõtete, tellimuste mudeli, blogipostituste ja artiklite kohta. Saate vaid ühe klõpsuga oma rolli heaolu konsultandina viia järgmisele tasemele ja rajada õnnelike ning toetatud klientide baasi. Täitke lihtsalt ostukorvid valitud toodetega ja jagage linki piiramatu arvu potentsiaalsete klientidega nii palju, kui ise soovite. Kõik tooted, mis te oma isiklikus veebipoes müüte, kantakse automaatselt teie isiklikule müügikontole. Veenduge vaid, et olete sisse logitud!


GoCore on meie ettevõttesisene juhiks kasvamise haridusprogramm, millele teil on ligipääs GoCore rakenduse abil. Kui harjutate ennast pidevalt arendama, jätkub ka teie äri kasv.
Juhendamine
Me soovitame teil kord kuus pidada nõu ülaliiniga, kes saab aidata teil oma tegevused ja tulemused üle vaadata ning äri arendamisega jätkata. Mida süstemaatilisemalt seda teha, seda lihtsam on tegevusi kontrollida ja kohandada. Leiate GoCore'i koolitusmaterjalid meie failiteegi Esmase koolituse (Get Started) teisest osast. Iga koolituse seanss peaks sisaldama õppetundi ühe meie juhtimisfilosoofia kohta. Igaühe kohta leiate video GoCore'i rakendusest.
„Näe rohkem vaeva iseenda arendamisega kui oma töö parendamisega...” Jim Rohn

Paljud sooviksid saavutada edu, kuid vähesed on valmis midagi selle nimel tegema. Me kõik oleme kuulnud lugusid väikesest lapsest, kes unistab maailma meistrivõistlustel mängimisest.
Need mõtted väljendavad soovi olla edukas. Ja isegi, kui see laps on oma eesmärgi suhtes ääretult innukas, ei pruugi ta teha vajalikku, et selleni jõuda. Lõpuks võib ta lihtsalt oma unistusele-saada jalgpallikuulsuseks käega lüüa.
Zinzinos usume, et edu on üles ehitatud headele harjumustele.
Me nimetame neid harjumusi järgmiselt: Zinzino meeskonna juhtimisfilosoofiad
„Tee asju, mida soovid näha dubleerituna“
Filosoofia 1: Väike eelis
Usume liitintressi põhimõtet, et kui iga päev midagi natuke teha, kasvab sellest kolme, viie või seitsme aasta jooksul väga suur äri. Ehkki puu kasvamist pole näha, on kogemusest teada, et ühel päeval 40 aastat hiljem on sellest väiksest puust saanud hiiglane.
Isiklik areng ja edukas ettevõte ei põhine mitte suurte riskide võtmisel, vaid igapäevastel väikestel tegudel.
Igapäevane tegutsemismeetod
... kuu
Igapäevased „väikese eelise“ tegevused
1 2 3
Juhised:
Täpsusta oma ülalnimetatud tegevusi.
Iga päeva puhul, mil viite kõik oma tegevused lõpule, märkige viimasest üks ruut üleval ja paremal.
Kui te ei lõpeta kõiki oma tegevusi, siis märkige üks ruut all ja paremal.

Filosoofia 2: Asjaarmastaja või meister
Meistrid keskenduvad sissetulekutele. Jalgpallivõistlusel võib olla 10 000 inimest: 9 960 neist on asjaarmastajad, kes staadionile pääsemise eest maksavad, 40 neist saavad seal olemise eest palka. Kõigil on hea meel seal olla ja väravate löömist näha, aga boonuse saab mängija, kes värava lööb. Zinzino meisterpartner töötab iga päev kolmes valdkonnas:
• Isiklike ja tiimiklientide hankimine
• Isiklike ja tiimipartnerite toetamine
• Tiimi juhtimise arendamine tulemuslikkuse püsivaks kahekordistamiseks
Filosoofia 3: Isikliku arengu toetamine
Kui te ei pea kinni isikliku arengu kavast, satute rütmi, kus alatasa alustate ja lõpetate. Kas olete teinud säästuhoiuse?
Kas olete seda raha kasutanud ühe korra või mitu korda? See on klassikaline alustamine ja lõpetamine. Kui palju oleks teie leeri- või kooli lõpetamise fond kasvanud, kui oleksite selle õigesse kohta investeerinud? Näeme, et inimesed, kes arendavad oma isiklikku arengut toetavaid oskusi on eesmärgikindlamad ja peavad plaanist paremini kinni kui need, kes end ei arenda. Võitja on see, kes teekonna läbi teeb.
See on tõsi nii maratoni, dieedi, säästuplaani kui ka ettevõtte arendamise korral. Eesmärgi saavutamiseks kuluv aeg pole kõige tähtsam. Kõige tähtsam on eesmärgi saavutamine.

Filosoofia 4: Väiksed võidud
Taaveti ja Koljati piibliloos tappis Taavet oma linguga esmalt lõvi. Lisaks tuli ta sama lingu abil võitjaks karu vastu. Kui ta jõuab sõjalaagrisse, kus iisraellased vilistidega sõdivad, kuuleb ta võimalusest võita palju kulda, kohaliku printsessi süda ja maksuvabastuse oma perele. See annab talle indu Koljatiga võidelda.
Tõenäoliselt ta kardab, aga ta kasvatab oma enesekindlust, mõeldes oma kahele eelmisele võidule, mis tuletavad talle meelde ta linguoskusi.
See annab talle julguse lahingus Koljatile vastu astuda. Ta võidab ja saab igaveseks legendiks.

Osav suhtleja keskendub osavale tegevusele, mis toob raha sisse.
Suures plaanis väikeseid eesmärke saavutades suurendame eneseusaldust. Väiksed võidud arendavad oskusi ja valmistavad meid ette suurteks ülesanneteks. Suure, 100 tellimust sooviva kliendi asemel otsime nädalas üht klienti. Suurt hakkame jahtima siis, kui meil on 25 klienti. Teisiti öeldes: „Väike võit“ on justkui „elevandi söömine ampsude haaval“.
Filosoofia 5: Suur asi vs. väike asi
Kui soovite tõesti kiiresti edu saavutada, peaksite hoiduma „suure asja“ lõksust. Tohutu tellimuste mahuga kliendi või esimese kuu jooksul 100 partnerit registreeriva tipp-partneri jahtimine ei too kaasa äri kahekordistumist. Zinzinos tähendab suur tehing mitmete väikeste tehingute sõlmimist. Tiimi luues leiate kiiresti 100 klienti. Meetod, kus üks partner toetab kahte partnerit, kes toetavad veel kahte partnerit, kes toetavad omakorda veel kahte partnerit, on parem kui üks partner, kes esimesel kuul toetab 100 partnerit. Võrgustikutegevus aitab partneritel saavutada väikseid eesmärke, mida paljud teised partnerid saavad samuti saavutada.
Kui teate mõnda suurettevõtte omanikku või inimest kes on edukas otsemüügi juht, soovitame lisaks kontaktiloendi põhjalikule läbitöötamisele nendega ühendust võtta. Zinzino majanduslik edu tuleb sellest, kui palju inimesi teeb pika aja jooksul korduvalt samu asju.
Filosoofia 6: Usk kõrgemasse jõudu – tiimisüsteem
Kahekordistamine pole alati lihtne. Me soovime õpetada ja kõike jagada, aga üks edu valemeid on viia inimesed iseseisvasse süsteemi, kus kõik saavad rohkem õppida. Kui teie huuled liiguvad, olete superstaar, kellest kõik sõltuvad.
Ühel hetkel pole teil enam aega meeskonda suurendada ja siis meeskond ei kasva. Eesmärk on hoopis näidata partneritele seda, mida nad ise tegema peavad. Tehke seda, mida soovite, et teised teeksid. 80% ajast peaksite tegelema uute ärivõimalustega, 20% ajast olemasolevate klientidega.

Filosoofia 7: Tehke tööd nutikalt, mitte raskelt
Tähtsad pole mitte töötunnid, vaid kasutatavad vahendid. Kui teil oleks võimalus teha tööd, kus saaksite mullahunniku teisaldamise eest tuhat eurot ja peaksite valima labida ja käru või kopplaaduri vahel, siis oleks targem valida suur masin ja teha töö ära mõne tunniga, mitte mõne päevaga, kui seda käsitsi teha. Tiimisüsteem on samasugune.
Kui te süsteemi tingimusi ei täida, peate kogu töö ise ära tegema.
Kui käite kohtumistel ja kasutate materjale, saate seda tööd teha koos teistega.
Varsti olete alustusjuhendi läbi töötanud. Kui teete palju tööd, kohtute paljude inimestega ning selgitate ja levitate seda, mida olete lugenud.
Kui töötate nutikalt, annate selle brošüüri kõigile oma tiimiliikmetele ja lepite nendega kokku, millal neil see läbi loetud peaks olema.
Neil, kes töötavad nutikalt, on süsteemis ja üritustel rohkem inimesi.
Filosoofia 8: Kultuuri loomine
Kultuur pole see, mida näeme, vaid see, kes me oleme. Reprodutseerime iseennast kogu aeg; kultuur võidab alati. Heaks näiteks on keeled. Oletagem, et teil on kümnest inimesest koosnev tiim ja piiramatu eelarve, et veenda
kõiki Pariisis elavaid inimesi loobuma prantsuse keelest ja asuma inglise
keelt rääkima. Kuidas see töötaks? Enne kui esimene prantslane inglise
keelt rääkima hakkaks, on kogu teie kümneliikmeline tiim prantsuse keele selgeks õppinud. Prantsuse kultuur on Pariisis tugevam kui Inglise kultuur, seega on tulemus ilmselge. Sama kehtib ka teie Zinzino ettevõtte kohta.
Kuidas sa lood kultuuri – näpunäited:
1 Jutuvestjad on osavad kultuuri loojad. Püüdke vastata küsimustele läbi lugude jutustamise. Neid on lihtne meelde jätta ja edasi rääkida. Meid motiveerivad alati lood edukatest inimestest.
2 Rääkige tõtt, aga olge tark. Inimesed saavad tõega hakkama isegi, kui see haiget teeb. Pikemas perspektiivis loob see usaldust, austust ja iseloomu.
3 Märgake, kui inimesed teevad asju õigesti ja kiitke neid selle eest. See tugevdab nende positiivseid külgi. Tehke seda teiste juuresolekul.
4 Positiivne suhtumine. Nähke alati kõiges parimat külge. Kui FedEx alustas oma esimest päeva, saadeti välja 157 pakki. 7 pakki jõudsid sihtkohta, millest 5 olid test-pakid. Sellepeale ütles firma asutaja Fred Smith: „Ära tegime!“ Nüüd peame lihtsalt numbreid parandama!“
5 Jaga tiimiga oma unistusi. Paljud kardavad astuda tundmatusse isegi siis, kui see tähendab nende jaoks paremat elu. Igaühes on suurepärasuse seeme olemas. Meie ülesanne on sellele seemnele vett ja soojust anda. Me kõik vajame inimesi, kes hoolivad. Kasvamiseks vajame sooja kliimat.
6 Jagage südamest. Rääkige asjadest nii nagu nad on. Meil saab raske olema, kui me ei palu teistelt oma probleemide lahendamiseks abi. Abi paludes on lihtsam tippu jõuda!


Filosoofia 9: Valeheadus
Kas olete kunagi lubanud iseendal või kellelgi teisel tähtsa koosoleku vahele jätta?
Sageli otsustame oma partnerite probleemid ise lahendada, selle asemel, et teha seda nendega koos. Arvame, et oleme heatahtlikud, aga tegelikult jätame nad ilma võimalusest saavutada edu. Arvame, et kui aitame neil väikestelt ostudelt või automaatsetelt tellimustelt raha kokku hoida, säästavad nad raha, et kiiremini edu saavutada. Sageli lubame neil mõnel üritusel mitte osaleda, sest nad ei saa seda endale lubada või neil pole selleks aega.
Kõik see on valeheadus. Tegelikkuses võtate neilt eduvõimaluse. Edu ei saa müüa. Selleks et teie partnerid oleksid edukad, peavad nad tegema sama, mida tegid teised, kes enne neid edu saavutasid ja nad peavad järgima kogu süsteemi tingimusi. Kui soovite, et teie tiimi saadaks tõeline edu, on teie ülesanne neile selgeks teha, mida on vaja teha ja neid innustada.
Filosoofia 10: Eeskuju näitamine
Hea juht on teistele eeskuju. Meie tiimis on ütlus: me ei palu kellelgi teha midagi sellist, mida me ise poleks nõus tegema või mida me ise juba teinud pole. Kui inimesed näevad teie eeskuju, siis nad teavad, et näitate neile ette kõike seda, mida soovite, et ka nemad teeksid. Seega on teie ülesanne igas olukorras näidata kogu organisatsioonile eeskuju. Nii loote usaldust, austust ja edu.
Filosoofia 11: Isiksusetüübid
Zinzinos töötades kohtame erineva iseloomuga inimesi. Vahel on neist erinevustest hea teadlik olla, et saaksite oma suhtlusstiili kohandada vastavalt suhtluspartnerile ja et tema ei peaks teie stiiliga kohanduma.
Et sellest oleks lihtsam aru saada, on erinevad isiksusetüübid meie õpetuses tähistatud nelja värviga Tom „Big Al“ Schreiteri käsitluses. Hr Schreiter on meie valdkonnas hästi tuntud ja edukas kõneleja, kes on seda teemat otsemüügiga seoses aastakümneid õpetanud. Teie isiksus on loomulikult nende värvide kombinatsioon ja mitte „ainult üks neist värvidest“, aga tavaliselt on meil üks domineeriv ja üks sekundaarne värv. Sama kehtib ka teie potentsiaalsete partnerite kohta. Lisateabe saamiseks kuulake GoCore'i rakenduse kaudu helifaili „Personality test –What color are you“, kus räägib Tom „Big Al“ Schreiter.
Kontrolliv ja konkureeriv isiksus
Pidutseja ja sotsiaalne isiksus
Analüüsiv isiksus
Hooliv isiksus
Kontrolliv ja konkureeriv isiksus: (Ametlik - domineeriv) Punased isiksused on domineerivad ja neile meeldib võistelda. Neile tavaliselt meeldib see, et teised inimesed töötavad nende heaks ja neil on meeskonnas ülemuse või liidri roll. Raha ja edu on sageli mõjuvaks motiveerivaks faktoriks, nii et väike nipp on neile varakult näidata, milliseid rahalisi võimalusi äris on. Neile meeldib tihti oma edukust näidata ja võivad vahel näida ülbed, pealiskaudsed ja vähese taktitundega. Samas on nad ülesandele ja tulemusele väga orienteeritud ning saavad asjad tehtud.
Pidutseja ja sotsiaalne isiksus: (Mitteametlik - domineeriv) Sinistele isiksustele meeldib pidu, lõbu ja seiklused. Neile meeldib sageli tähelepanu keskmes olla nii, et kõikide pilgud on talle suunatud. Nad ei ole niivõrd detailidest huvitatud ning nad tüdivad kergesti üleliigsetest faktidest ja organiseerimisest. Need on tüüpilised „inimeste inimesed“ – neil on tavaliselt suur sõprade võrgustik ja neil ei ole mingit probleemi teistega tuttavaks saada. Neid motiveerib raha, aga veel enam see, kui palju nad selle käigus lõbutseda saavad. Nad tahavad tulemust kohe, mitte tulevikus –soovitavalt eile!
Analüüsiv isiksus: (Ametlik – vooluga kaasas) Rohelistele inimestele meeldivad struktuurid, faktid ja detailid. Tavaliselt on neil palju küsimusi ning üldiselt tahavad hulga informatsiooni enne otsustamist. Nad on väga analüütilised ja eelistavad pigem liiga palju, kui et liiga vähe informatsiooni. Nad liituvad harva äriga esimesel kohtumisel, nad vajavad enne otsustamist mõtlemisaega ja tavaliselt hulga järelkohtumisi. Neid peetakse sageli alguses tagasihoidlikeks, aga nad on uskumatult lojaalsed, kui nad on ennast sidunud.
Hooliv isiksus: (Mitteametlik – vooluga kaasas) See isiksus ARMASTAB meeskonnas töötamist ja eelistab teha asju koos teiste inimestega, mitte omaette. Suhted on ülimalt olulised ja neil pole mingi probleem „teha üks lisaliigutus“, et aidata kellelgi teisel edu saavutada. Tavaliselt nad teevad palju rohkem, et aidata teistel, mitte endal edu saavutada. Neile ei meeldi vastuolud ja eelistavad, et nad teistele meeldiksid. Tavaliselt nad valivad hoolivaid erialasid ning nende suure tähelepanu all on enda ja teiste inimeste tunded. Tervis, perekond ja turvalisus on sageli prioriteedid. Nad on lojaalsed ja väga osavad oma meeskonna toetamisel.

Filosoofia 12: Tunnustamine
Kas olete märganud, et mõned inimesed „rabavad tööd teha“, et neid saavutuste eest tunnustataks? Paljude jaoks on see kõige tähtsam asi. „Tunnustuse nimel lapsed nutavad ja täiskasvanud on valmis surema.“
Pole tähtis, kes te olete või kui tagasihoidlik te olete – tunnustus tekitab hea enesetunde! Keegi ütleb: „Hästi tehtud!“. Tunnete end hästi. Teid premeeritakse raske töö eest.
Tunnete end väga hästi.
Kõigil meil on vajadus välja paista ja oma saavutuste eest tunnustatud saada, seega on meie alaliini ja ülaliini tunnustamine heade saavutuste eest üks hea tiimikultuuri loomise alustalasid. Kummalisel kombel pole inimesed tunnustusega eriti harjunud. Seetõttu on oskus tunnustada sageli midagi sellist, mida peame tiimi arendades õppima. Loomulikult on inimesi, kes oskavad märgata ja öelda, kui midagi on valesti, aga häid tulemusi, head tööd ja valdkonnas veedetud töötunde peetakse mõnikord iseenesestmõistetavaks.
Heaolukoolitaja ja võrkturundaja Randy Gage ütleb sageli, et võrkturunduses pole tähtsaim see, mis töötab, vaid see, mida on võimalik korrata. See on meie alal üldtuntud fakt, olgu siis tegemist sinu enda tulemuste, sponsoreeritud kontaktide, töötundide arvu või tunnustamise viisiga. Teie tegevust korratakse. Kui teie tunnustate oma tiimi, tunnustab teie tiim oma tiimi. Kui tunnustate oma ülaliini, tunnustab teie tiim teid. Veenduge, et kehtestaksite tiimis õige standardi ning jagaksite heldelt tunnustust. Kui annate ehedalt, siiralt ja ausalt tagasisidet, aitate end ümbritsevatel inimestel areneda.
Filosoofia 13: Tundke uhkust
End eduka inimesena näha pole alati lihtne. Juhtiv koolitaja
Patrick H. Dean üles kord, et tavaliselt takistab meid edu saavutamast kaks asja:
1 Arvatakse, et elus pole võimalused võrdselt jaotatud.
2 Lastakse end teiste arvamusest mõjutada.
Võtke paber ja pange kirja, miks olete uhke, et koos Zinzinoga töötate.
Tänu sellele saate üle hirmust, et mida teised inimesed arvavad.
Zinzinos on kõigil võrdsed võimalused.
Filosoofia 14: Kõige rohkem teenib see, kelle käes on marker
Passiivsus ei anna märkimisväärseid tulemusi. Rohkem teenivad need, kes võtavad vastutuse. Kui teie käes on marker, õpetate suurenevat tiimi.
See on eesmärk. Nüüd olete ettevõtte juht ja kahekordistamine võib alata.


Kirjanik ja koolitaja Norman Vincent Peale ütles kord: „Et saavutada midagi tähtsat, vajad sa natuke fantaasiat ja suurt unistust.“ Esimene samm suure ja kasumliku äri loomisel on aru saada, miks te seda teete. Korralikult põhjusest aru saamine on olulisem, kui aru saada, kuidas seda teha.
See käsiraamat on andnud teile kõige vajalikumad osad „kuidas teha“oskustest, mida vajate oma Zinzino äri arendamisel. Vaid üksikud ärid õpetavad, mis on sõna „unistus“ taga. Selle asemel räägitakse eesmärkidest, põhjustest, strateegiatest ja standarditest. Enamus inimesi leiab, et sõna „unistus“ on natuke laialivalguv. Kuid unistusi on mitmel tasandil. Kõige tavalisemad on materiaalsed unistused. Aga samas on palju ilmselgeid unistusi, mis on sügavad ja annavad elule mõtte.
On olemas unistusi isiklikul pinnal, kus soov on jätta pärand ja ajalugu järeltulevatele põlvedele. Kas unistus on suur või väike, üleliigne või sügav – tähtis on vaid see, millist mõju see avaldab selle unistuse omanikule. Unistus röövib tähelepanu ja domineerib mõtteid.
Kui te ei õpi kasutama unistuse jõudu ja seda, kuidas unistus mõjutab inimvõimeid, jätate te kasutamata elu ühe suurima kingituse.
Märkused
Et aidata teil leida oma unistused ja luua tulemusi, võtke pastakas ning vastake järgmistele küsimustele. Võtke oma aeg, tundke end hästi ja unistage!
1 Mida teeksite, kui teaksite ette, et ei saa oma tegemistes ebaõnnestuda?
(Teisisõnu - mida te teeksite, kui teie edu oleks garanteeritud?)
2 Milline oleks teie elu viie aasta pärast, kui saaksite selle ise kujundada?
Kirjeldage, millist elu soovite ja mõelge kõrval leheküljel välja toodud kuuele alale.
3 Mida meeldis teile teha lapsena, mida te alati olete tahtnud jätkata täiskasvanuna? Millisena tahate, et teid mäletataks?
On olemas sadu küsimusi, mida saab kasutada unistuste ülesleidmiseks, kuid esialgu piisab, kui võtate oma aja ja asute vastama ülaltoodud küsimustele.






Unistused ei ole fantaasiad
Siinkohal on oluline teid hoiatada. Oleme palju näinud, kuidas partnerid kirjutavad pikki nimekirju asjadest, mida nad „tahavad“. Nad räägivad suurtest majadest, kallitest autodest, imeilusatest puhkusereisidest, firmariietest ja aja veetmisest perega. Samuti räägivad nad oma jeti või hiiglasliku jahi ostmisest, reisist kuule ja Aafrika safarist. Aga kui me jõuame selleni, mida tuleb selleks teha, et see soovitu saavutada, jäävad nad parem oma tugitooli ja leiavad vabandusi. Need partnerid ei ole unistajad, nad koostasid just fantaasia nimekirja. See ei ole see, mida peame silmas, kui räägime unistustest. Kui panete kokku ühe fantaasiarikka nimekirja, ei motiveeri see teid kuidagi.
Kui me räägime unistustest, siis peavad need olema midagi sellist, mis räägivad teie südamega, mis puudutavad teid emotsionaalselt. See on midagi sellist, millest mõtlete nii päeval kui ööl. See miski annab teile energiat, et teha igapäevaseid tööülesandeid, ja distsipliini, et asjad lõpule viia.
Unistused ei ole tasuta
Unistused on väärtuslikud. Unistused on võimsad. Kuid unistused ei ole tasuta. Tõeliselt suur unistus saab teoks ainult läbi eneseohverduse, ehk mida oleme valmis selle saavutamiseks maksma. Seega, kui selgitate välja oma unistusi, on tähtis aru saada, kui palju olete valmis end selle saavutamiseks panustama. Kunagi ei saada „midagi mitte millegi eest“.
See kehtib ka teie Zinzino äri kohta. Tuleb panustada oma töösse. Tuleb kohustusi täita. Tuleb uusi asju õppida. Teil tuleb välja tulla oma mugavustsoonist, end veidi sirutada ja peate julgema tundma veidi ebamugavust, et oma unistus saavutada. Lõpuks tuleb tõdeda, et kogu see töö ja võetud kohustused ei ole äri hüvanguks, vaid on teie unistuse heaks. Ettevõte on lihtsalt töövahend teie unistuseni jõudmiseks. Me ei osta endale autot lihtsalt autoga sõitmise pärast.
Tahame autot osta, et teatud sihtkohta jõuda. Lisaks tahame, et autoga oleks lõbus sõita, et see näeks hea välja, oleks võimsa mootoriga ja sõidaks kiiresti. Sama on Zinzinoga. See on loodud, et meie unistusi täide viia. Teekond on väga lõbus, kuid peamine, et aitame teil oma unistusi täide viia. See nõuab targa töö tegemist, kuid see kõik on seda väärt, sest teie unistused on seda väärt.
Ootame suure rõõmuga, et saaksime alustada teie ja teie tiimiga koostööd ning nautida seda imelist teekonda üheskoos!

Lahtiütlus
Selle juhendi koostas Zinzino. Kõik õigused kaitstud. Koostajad ei vastuta trükijärgselt ilmnenud algmaterjali vigade, trükivigade ega muudatuste eest. Käsiraamatus soovitatud meetodid on osutunud edukaks paljude inimeste jaoks, kuid tulemused ei ole garanteeritud. Me loodame, et need meetodid annavad teile suurepärase alguse laiaulatusliku ja eduka äri ehitamiseks.
